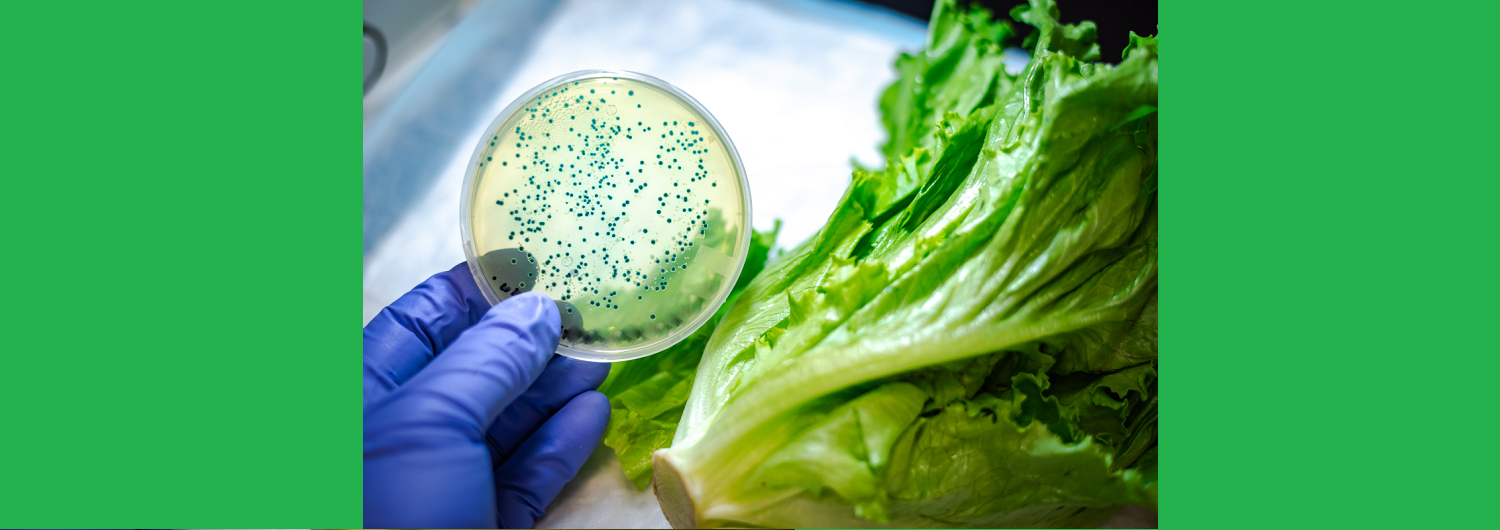

2025
Non in nostro nome
Trancemedia.eu propone
il "messaggio di pace e salute" già inviato a circa quarantamila destinatari
dal Movimento di lotta per la salute "Giulio Alfredo Maccacaro"
tramite RETE AMBIENTALISTA - Movimenti di Lotta per la Salute, l’Ambiente, la Pace e la Nonviolenza.
Tutti i link aprono (in nuova scheda) gli ARTICOLI COMPLETI, dal sito editore.
Movimento di lotta per la salute Giulio A. Maccacaro
Aggiornamento 11 marzo 2025
DISARM EUROPE! Sabato 15 marzo a Roma riuniamoci attorno alla bandiera della pace e del disarmo
Una manifestazione per questa Europa? Noi non ci saremo
“Dobbiamo riarmarci urgentemente”, ha detto Ursula von der Leyen, presidente della Commissione Europea. Non possiamo accettare un’Europa che alza il budget militare cancellando le vere conquiste europee. Ci siamo sempre battuti per l’Europa. Ma per un’Europa di pace, di diritti, di democrazia.
Lettera collettiva
https://www.peacelink.it/campagne/index.php?id=112&id_topic=2
Perché Trump, una volta eletto, ha mostrato fin da subito palese ostilità sia nei confronti di Gaza che dei suoi abitanti, ulteriore sostegno al controverso leader israeliano e ormai palese vicinanza strategica con gli interessi di Putin? Perché vuole evitare la terza guerra mondiale come ha detto pubblicamente a Zelensky? Perché l’Unione Europea sta sostenendo un piano di riarmo del vecchio continente di circa 800 miliardi di Euro? Per proteggere i suoi cittadini? E perché il presidente francese Macron offre a questi ultimi di estendere il proprio cosiddetto ombrello nucleare? Per tenerli al sicuro e scongiurare la guerra? In altre parole, è la pace che hanno a cuore costoro e più che mai coloro che sono alle loro spalle? Continua qui.
Europa e Russia non hanno alcun motivo per farsi la guerra
Per Jeffrey Sachs (già direttore dell’Earth Institute alla Columbia University) il conflitto in Ucraina è figlio “dell’arroganza statunitense”, un “tragico errore” frutto di 30 anni di politiche fallimentari che miravano all’espansione della Nato a est. Ma ora che l’America di Trump ha deciso di chiudere la ferita, la leadership europea sembra in preda alla coazione a ripetere e persiste su posizioni massimaliste che tendono a prolungare lo scontro. Arrivando fino a evocare lo spettro della deterrenza nucleare. L’Europa e la Russia non hanno alcun motivo per farsi la guerra se non per il bellicismo di una certa leadership europea, residuo della strategia di allargamento della Nato voluta dagli Stati Uniti tra il 1994 e il 2024. Continua qui.
La più grande rapina del secolo a danno dei più poveri va fermata
Ogni tre secondi, un essere umano muore di fame. Ogni tre secondi, un bambino, una donna o un uomo perde la vita perché non ha accesso al cibo. Eppure, i governi delle potenze mondiali continuano ad aumentare i bilanci militari, investendo cifre astronomiche in armamenti che, invece di garantire sicurezza e spesa sociale, alimentano instabilità e sofferenza. L’Europa vorrebbe aumentare la spesa militare di 800 miliardi di euro. Clicca qui.
Cinque passi di strategia nonviolenta contro la guerra
Ciò che sta avvenendo è la spartizione territoriale dell’Ucraina tra Russia e Stati Uniti, dopo tre anni di sanguinoso conflitto, un milione di morti, danni materiali ed economici incalcolabili, sofferenze ed impoverimento generale. La Russia otterrà l’espansione regionale in Crimea e Donbass, gli Stati Uniti metteranno le mani sulle “terre rare”, mentre l’Europa sta a guardare e l’Ucraina ne esce commissariata.
Questo è il risultato della scelta militare fatta, che ha trasformato l’intera Europa in una regione ad economia di guerra, a traino della Nato. La retorica del “prima la Vittoria, poi la Pace” si è rivelata per quello che era davvero: “prima la Guerra, poi la Sconfitta”. E a perderci, prima di tutti, è il popolo ucraino, che vede svanire la propria sovranità dopo aver sacrificato un’intera generazione di giovani sull’altare del nazionalismo.
L’Europa a 27 velocità, che ha accettato il ruolo di comparsa nell’Alleanza atlantica, è indebolita e afona. Per “salvare il salvabile” si vorrebbe ancora una volta puntare tutto sulla politica di riarmo, la stessa che ha distrutto il sistema sociale della sanità e dell’istruzione nei nostri paesi. Errore fatale. L’Europa, per affrontare la questione Ucraina, ha bisogno di una politica comune di sicurezza, pace e cooperazione, non di una politica di potenza e difesa militare, e deve avere una propria visione democratica alternativa a quella oligarchica di Stati Uniti e autoritaria della Federazione Russa.
Dunque sono cinque possibili passi necessari di strategia nonviolenta, per prevenire un’ulteriore escalation e per costruire una vera pace. Continua qui
Il Movimento Nonviolento
Pace, ovvero guerre ma solo con armamenti convenzionali
Appena avvertito di aver vinto il Premio Attila (https://www.rete- ambientalista.it/2025/03/06/ mattarella-nuovo-premio- attila/), Sergio Mattarella, da Hiroshima, devastata nel 1945 insieme a Nagasaki dalla bomba atomica, ha rivolto un monito alla “Federazione Russa, promotrice di una rinnovata e pericolosa narrativa nucleare, instillando l’inaccettabile idea che ordigni nucleari possano divenire strumento ordinario nella gestione dei conflitti”. Minacce che per il presidente “sono pronunciate con sconsideratezza inquietante”. Sconsiderata idea peraltro accettata da Trump. Secondo Mattarella, l’idea di guerre è considerata accettabile se con armamenti ordinari, come fece lui in Jugoslavia.
O, come si sta facendo, con armi italiane in Ucraina, dove anzi “Ora è ancora prematuro parlare di invio di truppe italiane”. O come si sta facendo a Gaza. Dove Israele non usa le atomiche che possiede, e vuole impedire che l’Iran le costruisca. Analogamente Mattarella lancia un altro monito: “Appare imperdonabile l’atteggiamento della Corea del Nord. Deve abbandonare immediatamente il proprio programma atomico e missilistico, e impegnarsi nel percorso della denuclearizzazione della penisola coreana”. Malgrado che, al sud della quale, navigano le portaerei nucleari americane.
Ora siamo pronti alla guerra atomica contro la Russia
Se ne parla da quasi dieci anni e ora sono realtà: le nuove bombe nucleari americane B61-12 (con potenza fino a 50 kiloton, tre volte più di Hiroshima) sono state inviate dagli Stati Uniti in Europa e quindi anche alle basi di Aviano e Ghedi. Si aggiungono a quelle offerte dal presidente francese Emmanuel Macron di estendere l’ombrello nucleare della Francia (240 armi strategiche) all’Europa. L’Inghilterra ne offre 120. Cinque nazioni Nato – Italia, Germania, Olanda, Belgio e Turchia – hanno sul loro territorio un totale di circa 100 ordigni nucleari americani. Tra questi cinque, l’Italia è il paese europeo con il numero più grande di armi nucleari statunitensi e l’unico con due basi nucleari: Aviano e Ghedi, rispettivamente con 20-30 e 10-15 ordigni).
La Russia possiede circa 7mila testate nucleari, tra strategiche schierate, riserve non distribuite, ritirate ma ancora intatte in coda per lo smantellamento. Al confronto, l’ombrellino europeo, senza l’ombrello americano, è miserino. L’unica speranza è che Trump e Putin vadano d’accordo.
Ma la Meloni è come Zelensky, non ha paura né della Russia né della Terza guerra Mondiale Nucleare, ritiene necessario aumentare le spese militari, tant’è che alla Conferenza degli Stati parti del Trattato sulla Proibizione delle armi nucleari che si è appena tenuta a New York, il governo italiano non si è neppure presentato. Questo trattato per mettere al bando l’atomica l’hanno già firmato o ratificato la metà degli Stati del mondo: 98 su 197, ma non l’Italia.
In Italia, l’ultimo sondaggio rilasciato da Archivio Disarmo rileva che – malgrado l’informazione dei Telemeloni – il 79% degli italiani interpellati è d’accordo nel proibire la detenzione di arsenali nucleari da parte degli Stati.
Noi pacifisti diciamo: fuori la Nato dall’Italia, fuori l’Italia dalla Nato.
_________________________________________________
Il Movimento di lotta per la salute “Giulio Alfredo Maccacaro” redige questo bollettino, che è distribuito tramite RETE AMBIENTALISTA – Movimenti di Lotta per la Salute, l’Ambiente, la Pace e la Nonviolenza.
Giulio Alfredo Maccacaro, scienziato militante
Biografia in breve di Giulio A. Maccacaro sul sito di Carocci Editore, nella pagina di presentazione del libro “Giulio Alfredo Maccacaro, scienziato militante”
di Domenico Ribatti, 2021
_________________________________________________
contenuti 7 marzo 2025
Ha sopravanzato concorrenti del calibro di Gennaro Sangiuliano, Giovanni Toti, Eugenio Giani, Francesco Lollobrigida, Carlo Nordio, Matteo Piantedosi, Gilberto Pichetto Fratin, Matteo Renzi, Stefania Battistini, Antonio Taiani, Roberto Vannacci. Per i quali anche forniamo, nelle pagine seguenti, un collage tra il serio e il faceto delle motivazioni che hanno sorretto le loro candidature. E, dopo i lusinghieri piazzamenti nelle passate edizioni nel premio, vince meritatamente
SERGIO MATTARELLA
“Mentre migliaia di magistrati con la Costituzione in mano escono dalle aule dell’anno giudiziario quando parlano i rappresentanti dello sgoverno, più di tante parole colpisce un silenzio: quello del presidente Sergio Mattarella, garante supremo della Costituzione e dunque anche del potere giudiziario”. Dal troppo silenzio alle troppe esternazioni: “Ma forse è meglio così: l’ultima volta che ha aperto bocca è stato per elogiare un ex premier pregiudicato per corruzione e finanziamento illecito che, dopo aver vilipeso la Giustizia del suo Paese, vi si era sottratto dandosi alla latitanza in Tunisia (Craxi). Non resta che rimpiangere Pertini, Scalfaro e Ciampi che, quando i governi attaccavano la magistratura, trovavano sempre il modo di farsi sentire e, quando ricevevano leggi indecenti e incostituzionali, le rispedivano indietro anziché firmarle”.
Soprattutto sono nel mirino le quotidiane esternazioni. Su pace e guerre. “Ha un bel coraggio, proprio lui, di parlare di settant’anni di pace in Europa rotta da Putin”. In effetti, nel 1999 un governo (D’Alema) da lui vicepresieduto bombardò per 78 giorni Belgrado: con la Nato e contro l’Onu, contro il diritto internazionale e la sovranità di uno Stato (la Serbia). Undici settimane di massacri, dai 1.200 ai 2.500 morti quasi tutti civili, fiumi di profughi, distrutta l’ambasciata cinese, polverizzati ospedali, scuole, zone residenziali, treni passeggeri, convogli di fuggiaschi, autobus, mercati, ponti affollati e gli studi della tv RTS (uccisi 16 fra registi, giornalisti e tecnici). Ma la Nato non la chiamò guerra, bensì “ingerenza umanitaria”. Quella brusca rottura della pace europea dopo 44 anni spalancò la strada a un’altra gravissima lesione del diritto: lo smembramento della Serbia con il riconoscimento dell’indipendenza del Kosovo contro la risoluzione dell’Onu n. 1244, che vi confermava la sovranità di Belgrado. In effetti, l’assenso di Mattarella si ripeté con le guerre illegali della Nato in Afghanistan (“lotta al terrorismo”), in Iraq (“esportazione della democrazia”) e in Libia (“sostegno alle primavere arabe”). Mattarella non fece mai paragoni con il Terzo Reich.
Lo fa ora contro la Russia, dopo che “fra il 2014 e il 2022 fu proprio lui a insignire delle massime onorificenze della Repubblica Italiana ben 30 ministri, funzionari e oligarchi putiniani, alcuni già sanzionati per la Crimea. Il tutto anni dopo le guerre russe in Cecenia e in Georgia, e i bombardamenti in Siria. Anzi, sul petto di Dmitry Peskov portavoce di Putin nel 2017 Mattarella appuntò la stella di Commendatore della Repubblica a Mosca. Senza però dimenticare il democristiano anticomunismo, quando “Denuncia l’ostilità di cui furono vittime gli esuli istriani ‘da parte di forze e partiti che in Italia si richiamavano alla stessa ideologia di Tito’, cioè il PCI, tra gli artefici della Costituzione italiana”.
Non passa giorno che non faccia esternazioni. A ruota libera, incurante della diplomazia. Ha tuonato contro le mire espansionistiche della Federazione Russa paragonandole a quelle che hanno connotato gli anni trenta del novecento e il disegno portato avanti da Adolf Hitler e dai suoi gerarchi: “Fenomeni di carattere autoritario presero il sopravvento in alcuni Paesi, attratti dalla favola che regimi dispotici e illiberali fossero più efficaci nella tutela degli interessi nazionali. Il risultato fu l’accentuarsi di un clima di conflitto… a prevalere fu il criterio della dominazione… e furono guerre di conquista… fu questo il progetto del Terzo Reich in Europa. L’odierna aggressione russa all’Ucraina è di questa natura”. A parte il dispregio alla diplomazia rivolgendosi ad una nazione che pagò milioni di morti per fermare la Germania, è evidente il fuorviante tentativo storico di equiparare l’aggressione di Putin alla lucida follia del fascismo tedesco che, se non fosse stato fermato proprio dall’Armata Rossa, si sarebbe espanso sino a conquistare tutto il mondo. Il tentativo è solo esercizio di propaganda bellica: non hanno senso i paragoni della Conferenza di Monaco con la situazione geopolitica attuale, solo gli stupidi o le persone in malafede come Zelensky possono dire -allo scopo di aumentare le spese militari- che la Russia attaccherà i Baltici… e arriverà a Lisbona (sic), cioè attaccherà la Nato.
“Per carità, rispetto a Biden, Mattarella è un pischello. Ma quando parla di guerre non pare lucidissimo. Anche a lui servono ripetizioni di storia. Esprime ‘grande tristezza nel vedere che il mondo getta in armamenti immani risorse finanziarie che andrebbero destinate a fini sociali’ (bene, bravo, bis). Poi però, con un arabesco logico da Guinness, ricasca nella solita litania: ‘L’Italia e i suoi alleati sostenendo l’Ucraina difendono la pace per evitare altre aggressioni a vicini più deboli che porterebbero a una guerra globale’. È la bugia che ci affligge dal 2022, quando Mosca invase l’Ucraina e si disse che la guerra era scoppiata quel giorno perché Putin, impazzito, voleva conquistare l’Europa partendo dal Donbass. Invece è scoppiata nel 2014, col golpe bianco di Euromaidan (fomentato dagli Usa, come confessò Victoria Nuland) per cacciare il legittimo presidente Janukovich e far eleggere il fantoccio Poroshenko che cambiò la Costituzione per aderire alla Nato e prese a bombardare il Donbass russofono ”. “Da buon ipocrita, naturalmente appoggia di spostare le risorse dal misero stato sociale italiano all’armamento bellico”.
Gennaro Sangiuliano
Agli italiani è andata male: avevano assicurato che Gennaro Sangiuliano era “l’uomo giusto” che avrebbe dato “una scossa alla Cultura” e invece si trovano come ministro della Cultura un ciuccio che fa ridere tutto il globo terracqueo coi suoi svarioni, detti ogni volta con la spocchia di chi si crede chissachi:
“Quando uno pensa a Londra pensa a Times Square”, “Dante è il fondatore del pensiero di destra in Italia”; “L’Inquisizione era un contropotere in Spagna”, “Colombo voleva raggiungere le Indie circumnavigando la Terra, sulla base delle teorie di Galileo Galilei”, che però nacque parecchi anni dopo. Quanti? Meloni: “Molti.”. Normale amministrazione, per un ministro che, da giurato allo Strega, andò in confusione davanti a Geppi Cucciari e rivelò di non aver letto i libri finalisti su cui aveva già votato. “Ma Sangiuliano non lo sa / che quando passa ride tutta la cittàààà!”, potrebbero swingare oggi le tre sorelle del Trio Lescano, con una rivincita postuma sui fascisti che le allontanarono dall’Italia poiché di famiglia ebraica. (Però chissà, magari oggi anche loro voterebbero fascio come tanti ebrei italiani.) Del resto, a quante cose sbagliate ci hanno fatto credere, da quando siamo al mondo?
Giovanni Toti
Nei primi anni 90 Giovanni Toti entra in Mediaset, raccomandato dal padre della fidanzata, per arruolarsi nella battaglia anti-giudici. La prestazione gli vale i galloni di caporedattore, poi vicedirettore, infine doppio direttore. Ricevute in dono da Berlusconi le mappe della intera Liguria – che dai tempi del boom economico mastica cemento, devasta le sue coste, i suoi borghi, nel cupio dissolvi del progresso esentasse – Toti s’avvale dell’alleato migliore, la solita sinistra divisa in tre liste, e nell’anno 2015 diventa governatore. Fabbrica il suo regno a suon di appalti, amicizie, propaganda. Si mette nella scia di Matteo Salvini, ma solo fino al disastro del Papeete, salendo sul salvagente che gli offre l’ex democristiano Maurizio Lupi, quello del Rolex. Dichiara: “La Liguria diventa il laboratorio nazionale dei moderati”.
Il laboratorio si inceppa. L’economia della Regione rallenta, i giovani non fanno figli e quando possono emigrano. Le panchine davanti al mare si riempiono di concittadini “non indispensabili allo sforzo produttivo”. A ogni cambio di stagione arriva la frana, l’incendio, l’alluvione a rallentare il bed & breakfast collettivo. A rinsaldare quel che la politica divide, arriva la tragedia nazionale del Ponte Morandi che distribuisce le carte della rinascita. Il cantiere è un successo. L’orgoglio dell’inaugurazione diventa la nuova fanfara del governatore che ormai frequenta solo le grandi barche e i grandi affari. Si è montato la testa e, come capita, la perde. Dopo 80 giorni agli arresti domiciliari nell’ambito dell’inchiesta sulla corruzione in Liguria, a due terzi del suo secondo mandato da governatore, Toti formalizza le dimissioni e patteggia.
A pensare che alla vigilia degli arresti il sistema Toti era in forma smagliante a fianco di Aldo Spinelli, il grande protagonista dell’indagine genovese: secondo i pm i finanziamenti erano collegati a favori portuali e immobiliari. Un fascicolo parallelo per corruzione riguarda anche l’imprenditore campano Colucci, che ha ottenuto dalla Regione Liguria l’ampliamento delle discariche che gestisce nel Ponente ligure. I Costantino hanno anche legami familiari con l’istituto Turtulici, attivo nella sanità privata. Fra liste d’attesa e fughe sanitarie da profondo Sud, la Liguria ha una delle peggiori sanità pubbliche del Nord Italia. Il gotha della sanità privata è tra i grandi donatori. Quanto alle aziende portuali, non c’è solo Spinelli fra i fan totiani, ma anche il socio amico-nemico Gianluigi Aponte. Un altro importante comparto è quello dell’edilizia, poi l’Esselunga eccetera.
Ultim’ora. “Avete visto il filmato di Trump su Gaza che sembra Dubai, con grattacieli e hotel? Sembra follia, ma dove si investe c’è lavoro e speranza. E la vita acquista un senso. E la violenza non è l’unica via. Forse, non è così folle!” (Giovanni Toti, su X, 26.2). Sta scontando la pena ai servizi socialmente inutili.
Eugenio Giani
Dopo circa un anno di trattative, Eugenio Giani, presidente della Regione Toscana, ha concluso con Enel Green Power uno “storico” accordo per il rinnovo delle concessioni minerarie geotermiche regionali per i prossimi 20 anni, evitando in tal modo alla società di andare a gara, con l’aiuto del governo Meloni e con grande gioia della multinazionale EGP. E gioca sull’equivoco e sulla disinformazione. Dichiara la risorsa geotermica“pulita, rinnovabile, sicura, a emissioni zero”, quando il suo stesso organismo regionale Arpat, nei periodici monitoraggi, certifica emissioni di grandi quantità di gas e sostanze tossico-nocive.
Ulteriore merito. La mancata attuazione del principio di precauzione in Amiata. Dopo 3 Studi sulla salute delle popolazioni locali, è stata evidenziata una grave situazione sanitaria (+ 13 % mortalità, + 19 % tumori con punte del 30 %), con ben 54 correlazioni tra incrementi di malattie e concentrazioni crescenti nell’ambiente di arsenico ed altri inquinanti che fuoriescono dalle centrali geotermiche. L’Amiata, oltre al bacino geotermico, dispone del più importante bacino acquifero della Toscana e dell’Italia Centrale con rinomati centri termali e varie sorgenti idropotabili che dissetano 700.000 persone di 3-4 province. Ebbene, la geotermia in Amiata, acqua-dominante, attraverso l’estrazione del vapore, sta depauperando l’acquifero come dimostra la falda che si sta abbassando. Le ricadute delle emissioni al suolo stanno creando, inoltre, potenziali rischi e pericoli per la qualità e la sicurezza dell’acqua destinata al consumo umano.
Giani campione infine di Democrazia. Ha condotto la trattativa con Enel GP nel massimo riserbo, secretando le varie fasi dell’accordo, a cui hanno potuto partecipare i soli sindaci dei 16 comuni geotermici, con l’obbligo di silenzio stampa. La trasformazione di un’area come l’Amiata di alto valore ambientale in area industriale geotermica obbliga il coinvolgimento delle comunità nei processi decisionali. Nessuna condivisione nonostante le ripetute richieste di incontro, mai una risposta alle diverse PEC. Una convocazione è avvenuta solo ad accordo firmato contravvenendo in pieno ai principi della legge regionale sulla partecipazione e della convenzione di Aarhus, che prevede la partecipazione del pubblico ai processi decisionali in materia di ambiente fin dalle fasi iniziali.
Francesco Lollobrigida
Francesco Lollobrigida, l’ex cognato che ferma i treni in ritardo in aperta campagna perché “si è sempre fatto così”, ha già una collezione di gaffe demenziali che l’ha reso celebre in tutto l’orbe terracqueo. Agli “Stati generali del Vino” il ministro dell’Agricoltura e Sovranità Alimentare ha affermato: “L’abuso di acqua può portare alla morte. E immaginate la necessità di un’etichettatura allarmistica sulle bottiglie d’acqua”. Al convegno dell’alimentazione sportiva: “Abbiniamo il consumo di vino al benessere fisico con gli eventi sportivi”. Alla fiera floricolturistica: “Le donne non si dovrebbero toccare nemmeno con un fiore e invece tratterò un argomento che è quello della produzione dei fiori”. In memoria della strage di Cutro: “Sono ignorante, non razzista. Ma non possiamo arrenderci all’idea della sostituzione etnica: gli italiani fanno meno figli, quindi li sostituiamo con qualcun altro?”. Al Vinitaly: “Vorrei imporre un piatto di formaggio nei menu dei ristoranti”. “In Italia la vitellina Mary viene trattata con affetto, poi certo viene macellata, ma produce carne di qualità”. Alla Caritas infine la celeberrima ricetta dietologica: “In Italia i poveri mangiano meglio dei ricchi”. A questo proposito annuncia: “Abbasso l’Iva sulle ostriche dal 22 al 10 per cento, perché non devono essere considerate un bene di lusso, ma un prodotto sano accessibile a tutti”(5 euro l’una); dopo di che i parlamentari si sono scatenati alla degustazione di ostriche “d’oro” (Golden oyster) in Senato, dove Ignazio La Russa ha gracchiato: “Gliela facciamo vedere noi al granchio blu”, che non è nero.
Carlo Nordio
Carlo Nordio, il ministro della giustizia all’italiana che vuole i test psicoattitudinali per i magistrati, svela che “i veri mafiosi non parlano al telefono” un attimo prima che Messina Denaro venga arrestato perché non riesce a staccarsi dal cellulare; poi incontra una giornalista di Sky e le chiede uno spritz; infine trinca nella masseria di Vespa e spiega che “il vino può essere un alibi per le eventuali sciocchezze che dico”, ma sia chiaro: “Bevo perché lo faceva il mio mito, che è Churchill”. Il sovraffollamento (quello non etilico) come lo si risolve? “Visto che gli stranieri rappresentano la metà dei detenuti sarebbe opportuno far scontare la pena nei loro paesi di origine, già avremmo risolto gran parte di questo problema, anzi – ha aggiunto – lo avremmo risolto totalmente”.
Matteo Piantedosi
Matteo Piantedosi è il ministro degli Interni che chiama i migranti superstiti della strage di Cutro “carichi residuali” (tipo cassa di patate). A partire dall’inchiesta dei giornalisti “infiltrati” di Fanpage sul movimento giovanile di Fratelli d’Italia, ha risposto in aula a un’interrogazione sulle iniziative per il contrasto ad ogni forma di apologia del nazifascismo e di propaganda dell’odio razziale, dell’omofobia e dell’antisemitismo, “con volontà di giungere allo scioglimento delle organizzazioni neofasciste e violente”.
Risposta: “La vergognosa ostentazione di gestualità e simboli di totalitarismi che la storia ha condannato, da parte di esponenti del movimento giovanile di FdI, così come i ripetuti incendi di bandiere israeliane nel corso di manifestazioni di piazza, gli assalti alle brigate ebraiche; le circostanze in cui è stato impedito a giornalisti di origine ebraica di prendere la parola in occasione di eventi pubblici, sono solo alcuni degli episodi che denotano un trasversale e inaccettabile rigurgito dell’antisemitismo che va combattuto su ogni fronte”.
Insomma, si è ben guardato dal soffermarsi sulle frasi razziste e apertamente nostalgiche nei confronti di nazismo e fascismo, pronunciate dai ragazzi di Gioventù Nazionale, sottovalutando volutamente gli atteggiamenti razzisti, antisemiti e apologetici del fascismo che permeano Gioventù Nazionale, minimizzando la pericolosità di quanto emerso dall’inchiesta di Fanpage , sostenendo sostanzialmente che le manifestazioni di critica e condanna delle politiche genocide di Netanyahu rappresentano la pericolosità maggiore.
Gilberto Pichetto Fratin
Gilberto Pichetto Fratin, ministro dell’Ambiente, ha consegnato al governo un Disegno di Legge per il ritorno della produzione di energia nucleare in Italia: giustamente la proposta è stata paragonata a una seduta spiritica, perché si prefigge di riportare in vita i morti.
Prefigura un “radioso” futuro per il Paese. Per radioso intende “radioattivo”. Lei parla di “nucleare sostenibile”. Potrebbe specificare sostenibile per chi? Perché se pensiamo ai rischi per i lavoratori impiegati, per i cittadini residenti nell’area circostante, per l’ambiente più in generale e per le generazioni future che dovranno gestire le scorie per migliaia di anni è difficile parlare di sostenibilità. Se invece intende sostenibile per le grandi imprese energivore e le mega-aziende hi-tech dell’Intelligenza Artificiale, è bene chiarirlo.
Lei parla di “centrali di nuova generazione, reattori piccoli, avanzati e modulari. Perché non dice anche che attualmente non esiste alcun prototipo in Occidente e che la quarantina in progetto in giro per il mondo sono stati giudicati fallimentari? Lei parla di “nucleare ad emissioni zero di Co2”. Ha per caso calcolato anche le attività di estrazione e trasporto dell’uranio, di costruzione e smantellamento delle centrali, di costruzione dei depositi per il trattamento delle scorie radioattive?
Lei parla di produzione di “energia nucleare come complementare alla transizione ecologica” basata sulle fonti rinnovabili, le quali, a suo dire, tenderebbero ad essere aleatorie. Quando invece tutti sanno che il costo del kWh elettrico si basa sull’ammortamento del capitale investito e quindi una centrale nucleare deve produrre il massimo possibile per tutto il tempo necessario; di conseguenza, più che complementare, sarà alternativa ed antagonista della produzione di energia da fonti rinnovabili.
Insomma, lei parla di “futuro del nucleare”, ma può dirci come pensa di risolvere il problema delle scorie prodotte dal nostro passato nucleare che dopo 50 anni non hanno ancora trovato una soluzione accettabile? E ci sta prendendo definitivamente in giro quando parla di “investimenti privati e di nessun onere per lo Stato” perché sa che tra le 411 centrali nucleari presenti attualmente sul pianeta nessuna è stata costruita senza fondi pubblici?
Matteo Renzi
Matteo Renzi è stalker comico (quello tragico è Zelensky) che fra le Europee e la Partita del Cuore era tornato al rango che gli compete: quello di pelo superfluo della politica. Poi l’astuto abbraccio di Elly Schlein l’ha catapultato dal campo santo al campo largo. E lui, appena gli dai un dito, si prende pure il coso, vabbè ci siamo capiti. Intima a Schlein e a Conte di mollare quel che stanno facendo per invitarlo subito, entro sera, a “un confronto senza veti”. Come se non fosse stato lui, nell’ordine: a porre il veto su Conte nel 2021, quando abbatté il governo progressista per riportare le destre al potere con Draghi e poi da sole; ad annunciare nel 2022 che “oggi finisce la storia del M5S, non parliamone più, torniamo alle cose serie, torniamo alla politica” e che “la fine del Pd sarà sia con Elly sia senza Elly. Ma se Elly Schlein diventa segretario, metà Pd passa con noi, e forse sono stato prudente”; a votare con le destre le schiforme della giustizia e la commissione sul Covid, cioè su Conte e Speranza.
I sondaggi dicono che sono più i voti che fa perdere di quelli che porta, ma lui è lì apposta: “Se io metto il veto sui grillini e i grillini su di me, vince Meloni”. Che “non risponde su nulla e cambia opinione su tutto”. Quindi dovrebbe piacergli un sacco.
Stefania Battistini
Dal presidente ucraino Zelensky onorificenza per Stefania Battistini (Tg1) – RAI Ufficio Stampa.
“Sono davvero onorata come giornalista del servizio pubblico di ricevere l’onorificenza che ieri il presidente Zelensky ha voluto attribuirmi come inviato di guerra. Un riconoscimento importante per il lavoro che il Tg1 e la Rai tutta hanno svolto in questi 9 mesi per coprire sul campo gli effetti dell’invasione russa in Ucraina”. Così Stefania Battistini, inviata del Tg1 in Ucraina, commenta l’onorificenza dell’Ordine della Principessa Olga, III grado, che il presidente ucraino Vlodymyr Zelensky le ha riconosciuto con un decreto. La motivazione dei riconoscimenti presidenziali – andati anche a rappresentanti dell’Unione Europea, ministri, sindaci, giornalisti ed esponenti di associazioni della società civile e del volontariato – è “per il significativo contributo personale al rafforzamento della cooperazione interstatale, al sostegno della sovranità dello Stato e dell’integrità territoriale dell’Ucraina, alla divulgazione dello Stato ucraino nel mondo”.
Tralasciamo il commento di Donald Trump.
Antonio Tajani
Antonio Tajani, erede del trono di Berlusconi, negli anni settanta fu vicesegretario del Fronte Monarchico Giovanile, ala junior dell’Unione Monarchica Italiana, la formazione politica vicina al ramo dei duchi d’Aosta della famiglia Savoia. Come già Vittorio Emanuele III, anche lui si esprime con comprensione nei confronti del Duce, come si può leggere qui sotto, ai microfoni del programma radiofonico “La Zanzara”, in onda su Radio 24.
“Mussolini? Fino a quando non ha dichiarato guerra al mondo intero seguendo Hitler, fino a quando non s’è fatto promotore delle leggi razziali, a parte la vicenda drammatica di Matteotti, ha fatto delle cose positive per realizzare infrastrutture nel nostro Paese, poi le bonifiche». «Da un punto di vista di fatti concreti realizzati, non si può dire che non abbia realizzato nulla”. Venti anni di fascismo all’ombra della monarchia non è poco, merita un di più.
Roberto Vannacci
Pier Luigi Bersani, imputato in sede penale per diffamazione aggravata nei confronti di Roberto Vannacci, allora generale dell’esercito e ora eurodeputato della Lega: l’ex segretario del Pd, durante un dibattito alla Festa dell’Unità di Ravenna, commentò il libro dell’ufficiale “Il mondo al contrario”: “Quando leggi quelle robe lì pensi: ‘Va bene dài, sciogliamo l’esercito, sciogliamo le istituzioni e facciamo un grandissimo bar’. Il Bar Italia. Dove puoi dare dell’invertito a un omosessuale, dove puoi dare della fattucchiera a una femminista, dove puoi dare del negro a un nero, dove puoi dire a un ebreo ‘ok la Shoah, ma non esageriamo’. Quel bar lì non sarebbe mai vuoto in Italia. Ma scusate, se in quel bar lì lui puoi dire tutte queste cose, è possibile dare del coglione a un generale? Se parlano da bar, dobbiamo parlare da bar anche noi. Quella non è critica al politicamente corretto, è arretramento della civiltà”.
Vittorio Emanuele
“Come vorrei essere ricordato? Ah, me lo chiede post mortem… vorrei essere ricordato come un buon padre di famiglia”. Vittorio Emanuele è morto a pochi giorni dal suo 87esimo compleanno. Era nato da Maria Josè e Umberto II, ultimo re d’Italia. Suo nonno Vittorio Emanuele III mise il Paese nelle mani di un dittatore, lo spedì in guerre coloniali feroci, accettò l’alleanza con il nazismo, firmò leggi razziste e antisemite, lasciò portar via migliaia di cittadini italiani ebrei, abbandonò centinaia di migliaia di soldati nelle mani dei nazisti e infine scappò con ignominia.
Anche Vittorio Emanuele, nel suo piccolo, ha generato tragedie (un suo colpo di fucile tolse la vita al giovane tedesco Dirk Hamer). Ma con lui la dinastia è passata dalla tragedia alla farsa. Ha potuto rimettere piede in Italia, ufficialmente, solo nel 2002. Ma Vittorio Emanuele è sempre stato dentro la storia italiana, quella invisibile e sotterranea, legata a lobby riservate, logge segrete, aristocrazie occulte impegnate in affari internazionali, spesso sul crinale tra legalità e illegalità. È stato piduista e mercante d’armi. Complessivamente un inetto.
Da giovane, fu playboy non brillantissimo e amante di fuoriserie con attitudine a uscire di strada (ciò gli valse il soprannome di Totò la Manivelle). Anche la carriera scolastica risultò un po’ difficile. In compenso fu cultore dello champagne e dei vini pregiati e collezionista di conchiglie. Prese anche il brevetto di pilota: acquistò un biplano con una sobria testa di tigre disegnata sulla fusoliera.
L’intera Rassegna dei Premi Attila dal 2004 (pagine 138) è disponibile a chi ne fa richiesta.
_________________________________________________
contenuti 3 marzo 2025
Solvay ringrazia Montecastello per grazia ricevuta
“E di trista vergogna si dipinse” (avrebbe detto Dante) il consiglio comunale di Montecastello, che ha deliberato di accettare i centomila euro di patteggiamento di Solvay. È come se, hanno esclamato gli ambientalisti, WWF, Greenpeace, Medicina democratica, mercanteggiassero con Solvay l’elemosina a beneficio di se stessi e di quei pochi cittadini che i loro avvocati rappresentano, quali parti civili nel processo di Alessandria (il secondo) per il disastro ecologico e sanitario, quasi fosse una specie di lotteria fra le centinaia di migliaia di persone della provincia. Sarebbe, infatti, un insulto etico e morale se Solvay se la cavasse elemosinando a poche decine di persone un “compenso per il metus”, cioè per la paura di ammalarsi, timore peraltro comune a tutta la popolazione provinciale, piuttosto che essere condannata a risarcire alle Vittime gli enormi danni per le malattie e le morti. Come incitò a fare, tramite class action, il Procuratore generale della Cassazione: “Questi (il management Solvay) dovete colpirli nel portafoglio.”
In forza di quella “grazia penale” concessa alla Solvay dal Consiglio comunale, i cittadini di Montecastello non saranno risarciti per i danni patrimoniali e non patrimoniali subìti avendo bevuto l’acqua avvelenata dai PFAS della Solvay, fino a quando il sindaco è stato costretto a chiudere l’acquedotto. I centomila euro a malapena coprono i costi, con tanto di mutui, sostenuti direttamente a collegare e tombare i pozzi idrici, in aggiunta a quelli sopportati dalla Regione. Il sindaco Gianluca Penna, “carte alla mano”, ha cercato di giustificarsi… esaltando i settemila euro, in aggiunta ai centomila, “strappati” a Solvay quale “danno di immagine”. Il vero danno di immagine è, semmai, quello che stanno sopportando con lo sconsiderato patteggiamento gli incolpevoli cittadini di Montecastello.
Nota Bene. Il patteggiamento di Montecastello o, peggio, di Alessandria, è in grado di condizionare le azioni giudiziarie penali e civili degli altri Comuni alessandrini della Fraschetta, dove è già stata rilevata un’allarmante presenza di Pfas, ad esempio Piovera, Castellazzo Bormida,…
L’offerta di Solvay a Comune e Regione per comprare la salute della popolazione
Ufficializzato il patteggiamento con il Comune di Montecastello (100mila euro), ora si attendono gli esiti delle trattative in corso tra Solvay e il Comune di Alessandria. Al quale, per uscire come parte civile dal processo sarebbero stati offerti altrettanti 100mila euro… “quale danno di immagine”. 1 milione sarebbe comunque oltraggioso a vendere la salute dei propri cittadini. 100mila, al pari del piccolo Montecastello, è addirittura irridente sul piano “contrattuale” considerando che ogni sindaco ha il potere, quale massima autorità sanitaria locale, di fermare precauzionalmente con ordinanza le produzioni inquinanti la salute della popolazione. Ma il sindaco di Alessandria, Giorgio Abonante, aveva già omesso questo dovere morale e istituzionale, oggi non più considerato un “debito esigibile”.
Solvay considera inoltre aggiudicata la complicità del sindaco che finge di non sapere che a Spinetta Marengo in giornate invernali si registrano concentrazioni di PFAS nell’aria di 1.000 volte superiori come ordine di grandezza ai valori assunti come riferimento, e resta inerme di fronte alle clamorose fughe di gas, come l’ennesima del 16 febbraio, gravissima perché riferita al micidiale perfluoroisobutene, che in passato ha ucciso. Clicca qui il commento dell’ex assessore Claudio Lombardi. Peraltro, la complicità di Abonante è data per scontata dopo le giustificazioni illegittime per un sindaco: “È l’Asl che mi deve ordinare la chiusura degli impianti”, mentre si nasconde dietro l’altrettanta complice Regione Piemonte, accusandola.
Per i danni inferti al territorio e alla popolazione piemontesi, Solvay dovrebbe pagare fior di miliardi in un processo secondo giustizia. Invece cerca di uscirne con un patteggiamento di qualche centinaio di milioni con la Regione Piemonte. Per preparare l’opinione pubblica alla scandalosa rinuncia di parte civile nel processo, è all’opera l’altisonante “Task Force” dell’imbonitore assessore regionale alla sanità, Federico Riboldi, con assemblee ad Alessandria che coinvolgano i Comitati. Invece di sottoporre finalmente ad un monitoraggio di massa fino a centinaia di migliaia di persone, la Regione appunto dichiara: “Non sono valori allarmanti” i livelli di Pfas nel sangue della popolazione, estraendo “un campione di 135 residenti entro 500 metri dal Polo Chimico di Spinetta” (29 nel primo step). Sono allarmanti, invece, anche in queste estrapolazioni.
Lo sono fingendo di ignorare che, per PFOA o ADV o C6O4, ecc per la salute l’unico valore sicuro nel sangue di tutti i Pfas è ZERO, e pur affidandosi ai “valori soglia” ufficiali. Lo sono perché, nel campione, TUTTE le persone hanno Pfas nel sangue, alcune addirittura superiori a 20 ng/ml. Se rapportiamo il dato al complesso della popolazione provinciale, la situazione sanitaria è catastrofica, altro che “non allarmante”. Infatti, per non allarmare – in cambio del fare cassa nel patteggiamento di una manciata di milioni – la Regione ha il compito di rallentare al massimo il monitoraggio provinciale. Per questa mistificazione mediatica la Regione si avvale di una “Commissione Clinica” appositamente da lei stessa nominata.
Il micro-monitoraggio per loro sarebbe “non allarmante” anche se – è allucinante! – “consigliano” “specialmente in popolazioni sensibili come le donne incinte, misure di riduzione dell’esposizione quali: utilizzare a fini alimentari le sole acque provenienti dall’acquedotto evitando le acque di pozzo, non utilizzare l’acqua di pozzi privati o da falda superficiale sia per uso domestico che per uso alimentare o agricolo, l’integrazione regolare nella dieta del consumo di alimenti di produzione propria o in generale locale, con il consumo di alimenti di provenienza diversa,” altro che chilometro zero, “considerare l’azione additiva di queste esposizioni con altre esposizioni a rischio (ad es tabacco, alcool, sedentarietà e alimentazione).
Gli “esperti” della Regione se ne lavano infine le mani consigliando ai Medici di base di consigliare alle persone “con valori superiori a 20 ng/ml nel sangue, poiché esiste un incremento del rischio di effetti avversi, di adottare le misure di riduzione dell’esposizione” licenziandosi o espatriando? “e procedere con una serie di analisi e alla raccolta di alcuni dati sulla vita delle persone”. È allucinante!
I processi italiani cruciali per il destino dei Pfas in Europa
I processi di Vicenza e Alessandria sono fratelli ma non gemelli: hanno grosse differenze. Quello di Alessandria è il secondo perché Solvay di Spinetta Marengo, malgrado la sentenza in Cassazione ha continuato a inquinare come prima e più di prima con 21 cancerogeni fra cui i PFAS e, invece di una conseguente pesante condanna per reiterato comportamento doloso e criminale, rischia addirittura di concludersi prima di iniziare con un assolutorio patteggiamento: un mercimonio di poche centinaia di milioni di euro anziché miliardi.
A Vicenza, invece, una dignitosa Procura, nel processo che sta per concludersi, disastro ambientale e avvelenamento delle acque, ha chiesto la condanna per dolo, “consapevolezza di avere inquinato senza prendere contromisure”, di 9 amministratori e manager (Miteni, Mitsubishi, ICIG) che si sono succeduti nella gestione PFAS della Miteni di Trissino: la pena più pesante è di 17 anni e sei mesi, la più tenue di 4 anni di reclusione. In totale le richieste di condanna raggiungono i 121 anni e 6 mesi di reclusione.
Solvay Syensko, unica produttrice di Pfas in Italia, ha bilanci in attivo stratosferici, Miteni invece è fallita e senza soldi per i risarcimenti (con o senza coperture assicurative). In comune i due processi hanno lontane anni luce le bonifiche non solo dal completamento ma pure dal concepimento: suolo-acqua-aria di 21 cancerogeni per Spinetta e, per Trissino, l’avvelenamento da Pfas della falda più grande d’Europa, in modo che i Pfas si sono trasferiti negli acquedotti finendo nei rubinetti delle case di decine di Comuni nelle province di Vicenza, Verona e Padova, coinvolgendo il sangue di 350mila persone, causando gravissime malattie e tumori: un’indagine epidemiologica ha quantificato in 4.000 le vittime in un arco di tempo di circa trent’anni.
Quali “bombe atomiche ad orologeria innescate” (definizione del pm Hans Roderich Blattner), il Veneto ha in comune con il Piemonte, che rimane ammantato da un alone di ambigua omertà, la catena delle responsabilità dei soggetti pubblici che avrebbero dovuto impedire che si materializzasse uno dei casi ambientali più gravi della storia recente del Vecchio continente.
A monte dei due processi epocali giganteggiano gli interessi in gioco. Sono colossali. I Pfas sono sostanze artificiali cruciali per una miriade di applicazioni: microprocessori e produzione bellica in primis. Scalfire gli interessi del complesso militare industriale è una sfida di non poco conto. In Italia la Solvay Syensko, unica produttrice di Pfas nello stabilimento di Spinetta Marengo, guida la lobby confindustriale che blocca una legge di messa al bando dei Pfas in produzione e consumo.
In Europa può esistere una maggioranza a favore del divieto totale, tuttavia la proposta di restrizione universale, avanzata da Danimarca, Germania, Paesi Bassi, Norvegia e Svezia, sta subendo un rallentamento inaccettabile a causa appunto delle lobby del settore chimico, che stanno investendo milioni per bloccare il divieto. L’esito dei due processi italiani diventa dunque cruciale.
2mila miliardi di danni. La lobby dei Pfas e l’inciucione italiano
Rispetto a quando per la prima volta (1990) scrivemmo che lo stabilimento di Spinetta Marengo scaricava Pfas in Bormida… Clicca qui
CIVG Centro di iniziative per la verità e la giustizia”.
Lunga storia di connivenze, complicità, corruzioni, ignavie…
… di Comune, Provincia, Regione, governo, Asl, Arpa, sindacati, magistratura e giornali. Clicca qui La bottega del Barbieri
Lunga storia dei PFAS (PFOA e C6O4 e ADV) dello stabilimento Montedison-Solvay di Spinetta Marengo (Alessandria) da stralci dei libri «Ambiente Delitto Perfetto» (Barbara Tartaglione-Lino Balza, prefazione di Giorgio Nebbia) e «L’avventurosa storia del giornalismo di Lino Balza» nonché del sito “Rete Ambientalista Movimenti di lotta per la salute, l’ambiente, la pace e la nonviolenza” gestito dal “Movimento di lotta per la salute Giulio A. Maccacaro”.
Seminario Casacomune del 23/02/2025
“Ammaliamo il mondo. La salute al primo posto?”
Clicca sul titolo la relazione di Lino Balza sui Pfas.
Il momento è arrivato! La liberazione di Ocalan, il Mandela del popolo kurdo, insieme a quella di Marwan Barghouti per la Palestina, è la chiave di volta per la liberazione del Medio Oriente. (Clicca qui)
Venti proposizioni da ricordare non solo per l’otto marzo
La prima radice di ogni altra violenza e oppressione è la dominazione maschilista e patriarcale che spezza in due l’umanità e nega piena dignità e uguaglianza di diritti a metà del genere umano, e così disumanizza l’umanità intera. Solo abolendola… (Continua)
Povertà e disuguaglianza per le famiglie con disabili
La spesa privata degli italiani per il “welfare familiare” (salute e assistenza ad anziani e persone con disabilità) nel 2024 è stata di circa 138 miliardi di euro, ovvero quasi 5.400 euro per ciascun nucleo! Inoltre povertà e disuguaglianza, che i servizi di welfare sono chiamati a limitare, stanno peggiorando e particolarmente grave è la situazione delle famiglie con persone con disabilità. Sono alcuni dati che emergono dal Rapporto della Fondazione per la Sussidiarietà… Clicca qui “Welfare familiare”: 138 miliardi di euro per la spesa privata degli italiani
L’UE abbandona la lotta contro la discriminazione
La revoca da parte della Commissione Europea della Proposta di Direttiva sulla Parità di Trattamento «mina gravemente l’impegno dell’Unione Europea verso l’uguaglianza, i diritti umani e il processo decisionale democratico»: lo denuncia l’EDF, il Forum Europeo sulla Disabilità, che insieme ad altre otto organizzazioni invita la stessa Commissione Europea a cambiare rotta urgentemente. L’EDF, il Forum Europeo sulla Disabilità, insieme ad altre otto organizzazioni impegnate per i diritti umani… (continua)
L’Unione Europea non può e non deve abbandonare la lotta contro la discriminazione!
No all’autorizzazione a produrre nello stabilimento Ilva
In assenza di garanzie per la salute pubblica e in presenza di un parere così netto dell’Istituto Superiore della Sanità.
Infatti, afferma Peacelink, l’azienda Acciaierie d’Italia aveva commissionato uno studio per valutare l’impatto sanitario delle emissioni in uno scenario produttivo di 6 milioni e di 8 milioni di tonnellate di acciaio annue, sostenendo che, grazie all’adozione delle migliori tecnologie disponibili (BAT), le emissioni “post operam” sarebbero rientrate – in entrambi gli scenari – sotto la soglia di rischio accettabile. Ma l’ISS ha sollevato puntuali obiezioni sulla metodologia adottata. Questa presa di posizione dell’ISS rappresenta un segnale forte. La VIS commissionata dall’azienda presenterebbe per l’ISS criticità metodologiche che porterebbero a una sottostima del rischio sanitario effettivo. Taranto ha diritto a un futuro libero dalla spada di Damocle dell’inquinamento mortale per costruire un futuro di sviluppo sostenibile.
No all’aumento delle spese militari
Clicca qui PeaceLink.
Sistema sanitario al punto di non ritorno
La Fondazione Gimbe lancia l’allarme: “La tenuta del sistema sanitario è vicina al punto di non ritorno.” Un divario della spesa sanitaria pubblica pro capite di € 889 rispetto alla media dei paesi OCSE membri dell’Unione Europea, con un gap complessivo che sfiora i € 52,4 miliardi; la crisi motivazionale del personale che abbandona il SSN; il boom della spesa a carico delle famiglie (+10,3%); quasi 4,5 milioni di persone che nel 2023 hanno rinunciato alle cure, di cui 2,5 milioni per motivi economici; le inaccettabili diseguaglianze regionali e territoriali; la migrazione sanitaria e i disagi quotidiani sui tempi di attesa e sui pronto soccorso affollati. Nino Cartabellotta, presidente della Fondazione GIMBE, ha presentato il rapporto sulla crescita della spesa sanitaria privata in Italia. (Continua qui)
_________________________________________________
contenuti 22 febbraio 2025
Trump putiniano, anche lui. Tra poco anche Meloni
Entrambi con pollice recto.
“Dittatore senza elezioni, Zelensky farebbe meglio a muoversi in fretta o non gli rimarrà un Paese”. “Un dittatore mai eletto”, “un comico mediocre” che “rifiuta di indire elezioni, è molto giù nei sondaggi ucraini (4%) e l’unica cosa in cui è stato bravo è l’aver suonato Biden come un violino”. “Beh, sei stato lì per tre anni. Avresti dovuto chiuderla dopo tre anni. Non avresti mai dovuto iniziarla. Avresti potuto fare un accordo”. “Pensateci, un comico di modesto successo ha convinto gli Stati Uniti d’America a spendere 350 miliardi di dollari, per entrare in una guerra che non poteva essere vinta, che non avrebbe mai dovuto iniziare, ma una guerra che lui, senza gli Stati Uniti e Trump, non sarà mai in grado di risolvere”. Anzi, “Zelensky ammette che metà dei soldi che gli abbiamo inviato sono mancanti”, “probabilmente vuole mantenere in funzione il treno della cuccagna”. In passato Donald Trump lo aveva già definito sarcasticamente come “il miglior piazzista sulla terra: ogni volta che viene in Usa se ne va con 60 miliardi.
Torna ad attaccarlo Elon Musk: “Zelensky non può affermare di rappresentare la volontà del popolo ucraino a meno che non ripristini la libertà di stampa e smetta di cancellare le elezioni!”.”In America teniamo elezioni presidenziali ogni quattro anni, anche in tempo di guerra. Abbiamo tenuto elezioni durante la guerra civile. Abbiamo tenuto elezioni durante la seconda guerra mondiale. Prima che il presidente Zelensky decida di fare di nuovo la predica al presidente americano, dovrebbe tenere elezioni anche lui”.
Zelensky ha replicato dando ad entrambi dei putiniani. L’epiteto era stato ripetuto per anni nei confronti dei pacifisti che sostenevano trattative, piuttosto che l’invio di armi di Meloni & Co. per “una guerra fino all’ultimo ucraino”.
Perchè Meloni vuole aumentare le spese militari italiane alla UE?
Se è vero, come scrive l’Agenzia europea di difesa, che le spese miliari sono già arrivate a 279 miliardi di euro nel 2023 e si prevede arriveranno a 326 miliardi nel 2024 con un rapporto sul Pil che passa dall’1,6 all’1,9%, si tratta di un aumento del 30% in poco più di due anni e che colloca la spesa dei 27 Stati Ue accanto alla Cina (278 miliardi) e molto più avanti della Russia, terza con 102 miliardi di euro. Un rapporto più che vantaggioso che sembra confermato anche dall’analisi dei mezzi e degli uomini a disposizione. Perché? vuole attaccare guerra alla Russia non più per interposta Ucraina? È un suicidio: commenta la vignetta di Vauro.
I Pfas non dovrebbero mai trovarsi nei giocattoli per bambini
Secondo l’Associazione Italiana Medici per l’Ambiente-Isde e l’Associazione Culturale Pediatri-Acp, i Pfas continuano a essere presenti nei prodotti destinati ai bambini, con il rischio di gravi conseguenze sulla loro salute. Isde e Acp hanno inviato una lettera ai ministri della Salute e dell’Economia per chiedere di vietare l’uso di Pfas e bisfenoli, già banditi dagli imballaggi alimentari in diversi Paesi, ma ancora ammessi nei giocattoli. Le evidenze scientifiche sono schiaccianti: i Pfas sono sostanze che indeboliscono il sistema immunitario, riducono l’efficacia dei vaccini e aumentano il rischio di malattie croniche, sono stati rinvenuti nelle urine dei bambini di tutta Europa e sono associati a problemi di sviluppo, obesità e persino tumori.
La partita ora si gioca nei palazzi della politica, tra pressioni industriali, in particolare di Solvay che, nello stabilimento di Spinetta Marengo, è l’unico produttore italiano di Pfas. Sono scelte che definiranno il livello di tutela per le nuove generazioni.
Il tema della “qualità” dell’acqua è tornato alla ribalta dopo la pubblicazione, da parte di Greenpeace, di una mappa a livello nazionale della contaminazione da Pfas nelle acque potabili con prelievi prevalentemente fatti da fontanelle pubbliche: nell’analisi di Arzignano erano state trovate concentrazioni maggiori rispetto alle altre città del Veneto prese in considerazione. A fronteggiare la situazione l’amministrazione ha installato 27 casette dell’acqua, che sono provviste di filtri a carbone attivo.
Queste sono le migliori padelle senza PFAS
Clicca qui: https://www.greenme.it/ lifestyle/sai-cosa-compri/ queste-sono-le-migliori- padelle-senza-pfas-per- cucinare-i-tuoi-cibi- preferiti-in-modo-piu-sano-e- sicuro/
Padelle antiaderenti o in ceramica?
Clicca qui: https://ilsalvagente.it/2025/ 02/02/padelle-antiaderenti-o- in-ceramica-le-differenze-in- laboratorio/
Il “caso Pfas” spiegato nelle scuole
Se possiamo dare un suggerimento a Greenpeace e a chi ha le disponibilità finanziarie per farlo, è avviare nelle scuole italiane l’esperienza del Liceo scientifico G.B. Quadri di Vicenza, nel corso della quale sarà anche affrontato il caso Miteni e l’inquinamento da PFAS, accompagnato dalla visione di Dark Waters. Sarà raccontato ai ragazzi l’impatto dell’inquinamento ambientale legato al caso Miteni di Trissino, un disastro che ha coinvolto profondamente il territorio vicentino. Grazie alla sua esperienza come giornalista d’inchiesta, Marco Milioni offrirà una prospettiva unica sul rapporto tra ambiente e responsabilità collettiva. Il progetto vicentino non solo forma, ma stimola il pensiero critico e l’interesse per il giornalismo investigativo, coinvolgendo attivamente studenti e istituti del territorio. Clicca qui.
I Pfas nel sangue della madre in gravidanza
ll team di ricerca ha utilizzato i dati dell’indagine Ecochill per studiare l’effetto della concentrazione di PFAS nel sangue della madre nella gravidanza, dall’inizio alla metà della gravidanza. Clicca qui.
Volo di Stato per onorare il latitante
Cliccando sul titolo: La vignetta di Mario Natangelo pubblicata in prima pagina su Il Fatto Quotidiano è stata “rimossa” da Facebook dopo dieci minuti di pubblicazione per violazione degli alti standard dei contenuti di Meta.
Non era bastata la parata di politici per ricordare Bettino Craxi, storico leader socialista scomparso latitante dopo essere fuggito dai processi di Tangentopoli (che comunque gli sono costati condanne definitive per corruzione e finanziamento illecito). Ora si scopre che per portare gli omaggi a Craxi ad Hammamet, in Tunisia, è stato utilizzato il volo di Stato, cioè l’aereo blu pagato con i soldi dei contribuenti. Lo ha fatto, come certifica il database dei voli di Stato della Presidenza del Consiglio, il 18 gennaio scorso il ministro degli Esteri e vicepremier Antonio Tajani. Quest’ultimo il 17 e 18 gennaio era partito per Berlino per partecipare a un ricevimento all’ambasciata italiana e a un vertice del Ppe, per poi fare scalo ad Hammamet il giorno successivo, poi a Catania per assistere alla prima del teatro Bellini e tornare a Roma. A colpire è il passaggio in Tunisia per il 25esimo anniversario dalla morte di Craxi. Obiettivo: portare “il saluto del governo e rendere omaggio a un grande italiano che è stato protagonista della nostra vita politica, ingiustamente criminalizzato”. E ancora, il tocco poetico: “Craxi, Andreotti e Berlusconi sono stati i grandi strateghi di politica estera”.
La salute al primo posto. Cosa fare
Clicca qui il programma. In particolare, per il CASO PFAS: sabato 22 febbraio Vincenzo Cordiano e Vitalia Murgia (ISDE); domenica 23 febbraio Comitato mamme no Pfas, Lino Balza Movimento di lotta per la salute Maccacaro. A Torino, alla Fabbrica delle E, Corso Trapani 91b.
“L’Italia ripudia la guerra”… dipende contro chi
“Auspico che la Russia torni a svolgere un ruolo di rilievo nel rispetto della sovranità di ogni Stato, della carta dell’Onu e del diritto internazionale”: giuste parole ma non sulla bocca di Sergio Mattarella. Nel 1999 un governo da lui vicepresieduto bombardò per 78 giorni Belgrado con la Nato e contro l’Onu, il diritto internazionale e la sovranità di uno Stato: la Serbia alleata di Mosca. Undici settimane di massacri, dai 1.200 ai 2.500 morti quasi tutti civili, fiumi di profughi, distrutta l’ambasciata cinese, polverizzati ospedali, scuole, zone residenziali, treni passeggeri, convogli di fuggiaschi, autobus, mercati, ponti affollati e gli studi della tv RTS (uccisi 16 fra registi, giornalisti e tecnici). Ma la Nato non la chiamò guerra, bensì “ingerenza umanitaria”. Quella brusca rottura della pace europea dopo 44 anni spalancò la strada a un’altra gravissima lesione del diritto: lo smembramento della Serbia con il riconoscimento dell’indipendenza del Kosovo contro la risoluzione dell’Onu n. 1244, che vi confermava la sovranità di Belgrado.
La scena si ripeté con le guerre illegali della Nato in Afghanistan (“lotta al terrorismo”), in Iraq (“esportazione della democrazia”) e in Libia (“sostegno alle primavere arabe”). Mattarella non fece mai paragoni con il Terzo Reich. Lo fa ora dopo che fra il 2014 e il 2022 fu proprio lui a insignire delle massime onorificenze della Repubblica Italiana ben 30 ministri, funzionari e oligarchi putiniani, alcuni già sanzionati per la Crimea. Il tutto anni dopo le guerre russe in Cecenia e in Georgia e i bombardamenti in Siria. Anzi, sul petto di Dmitry Peskov portavoce di Putin nel 2017 Mattarella appuntò la stella di Commendatore della Repubblica a Mosca.
Il nuovo pacchetto di riforme scolastiche proposto dal governo Meloni, guidato dal Ministro dell’Istruzione e del Merito Giuseppe Valditara, hanno sollevato critiche da più parti. Le riforme, che includono il voto di condotta come strumento punitivo, l’accelerazione dei percorsi tecnici e l’alternanza scuola-lavoro obbligatoria, hanno sollevato un acceso dibattito e numerose proteste.
Meloni e Valditara promettono “di rivoluzionare il sistema educativo”, ma rischiano di trasformare le aule in campi di battaglia. Tra voto di condotta usato come arma, istituti tecnici accelerati e piegati agli interessi delle aziende e alternanza scuola-lavoro obbligatoria, il pacchetto di misure divide il Paese, scatenando proteste da parte di docenti e studenti. Clicca qui.
Caligo e maccaja sul porto di Genova
Il futuro della nuova diga foranea del porto di Genova, la più costosa opera portuale mai realizzata in Italia (1,3 miliardi tutti pubblici, di cui 500 dal fondo complementare al Pnrr e oltre 250 dalla Banca europea degli investimenti) si fa ancora più nebuloso: la trasparenza sui fondi e le incognite sulla progettazione.
L’incognita principale, emersa durante la progettazione, e fulcro delle incongruenze dell’appalto cui sta lavorando la Procura, attiene alla tenuta dei fondali (93) su cui, a profondità da record, si intende far correre i 6 chilometri della diga: realizzati in cemento armato, sono veri e propri giganti, grossi come palazzi, vengono posati uno accanto all’altro sul basamento sommerso.
La nuova Diga foranea è progettata per consentire al Porto di Genova di ospitare in sicurezza navi più grandi, senza limitare gli accessi e le manovre verso gli accosti, e adeguandosi alle esigenze delle maggiori compagnie di navigazione. Senza questo intervento, il Porto di Genova perderebbe progressivamente parte del traffico attuale e non sarebbe in grado di intercettare nuovo traffico. Si obietta che il traffico di container ristagna in Italia da 15 anni, e dove già si possono accogliere le mega-navi di ultima generazione (Vado Ligure, Genova Pra, Trieste) i tassi di utilizzo dei terminal oscillano fra il 25 e il 65%.
Per il Premio Attila 2024 votate entro il 28 febbraio
Dopo quelle già pubblicate, Meloni, Tajani, Sangiuliano, Toti, Craxi, Mattarella, Zelens’kyj, Battistini, Vittorio Emanuele, Vannacci, Musk, Nordio, Picerno, Renzi, Brugnaro, sono pervenute ulteriori candidature: Matteo Piantedosi, “il ministro degli interni che dimentica di soffermarsi sulle frasi razziste e apertamente nostalgiche nei confronti di nazismo e fascismo, pronunciate dai ragazzi di Gioventù Nazionale”. Aldo Spinelli, “Scampa alle manette di Mani pulite confessando al giudice una tangente di mezzo miliardo di lire alla Democrazia Cristiana, abbandona la protezione del ministro Prandini che gli era valsa la presidenza della società del traforo del Frejus, cura assiduamente i rapporti politici con il Psi di Craxi e infine con il Pds e poi Ds di Burlando, approdando padrone del porto di Genova infine alle Mani pulite di Toti”. Antonio Tajani, “Vicesegretario del Fronte Monarchico erede del trono di Berlusconi: «Mussolini? Fino a quando non ha dichiarato guerra al mondo intero seguendo Hitler, fino a quando non s’è fatto promotore delle leggi razziali, a parte la vicenda drammatica di Matteotti, ha fatto delle cose positive per realizzare infrastrutture nel nostro Paese, poi le bonifiche».”
L’intera Rassegna dei Premi Attila dal 2004 (pagine 125) è disponibile a chi ne fa richiesta.
_________________________________________________
contenuti 12 febbraio 2025
Politici, stop patteggiamenti con Solvay sulla pelle della gente
“I Comitati e le Associazioni invitano la Procura di Alessandria a non intraprendere procedimento di patteggiamento con Solvay/Syensqo inteso a favorire in senso premiale all’imputato di chiudere anticipatamente senza dibattimento la vicenda penale relativa al disastro ecosanitario dello stabilimento di Spinetta Marengo.”
“I Comitati e le Associazioni diffidano le Istituzioni locali e nazionali (Comune, Regione, Ministero ecc.) di proseguire tavoli di trattative intesi a favorire tale patteggiamento che affievolisce i reiterati reati penali e civili di contaminazione ambientale e non riconosce alle Vittime, persone fisiche morte o ammalate, i reali risarcimenti rapportati ai danni individualmente subìti”.
“I Comitati e le Associazioni, a discrimine di ogni ipotesi di patteggiamento, pongono irrinunciabilmente al primo posto l’immediata interruzione della condotta di contaminazione che continua a perdurare, cioè pongono l’arresto della produzione e dell’utilizzo delle sostanze tossiche e cancerogene: con l’azzeramento delle emissioni in aria, nel sottosuolo e in falda e col procedere contestualmente – a carico dell’azienda – ad una reale e completa bonifica dell’inquinamento fino ad oggi generato”.
Su questi tre imperativi etici e politici – in primis fermare Solvay – hanno concordato i gruppi locali dei Comitati e delle Associazioni di Alessandria, impegnandosi ciascuno ad articolare all’opinione pubblica prese di posizione forti e inequivocabili nei confronti delle Istituzioni, in grado di mobilitare la popolazione e fare blocco sulla Procura.
Così, hanno proceduto con comunicati stampa Legambiente (clicca qui) e Movimento di lotta per la salute Maccacaro (clicca qui). Così, proseguiranno le prese di posizione di WWF, Comitato Stop Solvay, Medicina democratica, Vivere in Fraschetta, Greenpeace, Anemos,… Aspettando i Sindacati e i Partiti.
Le parti civili a cui Solvay propone di vendere la salute della popolazione
La Solvay (Syensqo) ha ottenuto dal GUP di Alessandria il rinvio dell’udienza di sei mesi allo scopo di addivenire ad un patteggiamento premiale con la Procura della Repubblica, ovvero di chiudere anticipatamente senza dibattimento la vicenda penale relativa al disastro ecosanitario dello stabilimento di Spinetta Marengo. Allo scopo, i sei mesi servono alla Solvay per concludere trattative con le Parti civili, affinché le stesse esprimano eventuale assenso alla Procura della Repubblica.
I nodi da sciogliere con le Parti civili riguardano minimamente le PARTI CIVILI FISICHE. Queste persone, infatti, sono un paio di centinaia ammesse con discriminazione al processo: non si giustifica perché alla stregua non siano ammesse le decine di migliaia di alessandrini, magari vittime di malattie e morti. Ebbene, Solvay reputa che queste persone, scontando che non hanno nessuna fiducia nella Giustizia, si accontenteranno dell’elemosina di poche migliaia di euro, mentre le parcelle degli avvocati sarebbero una cuccagna.
I nodi da sciogliere riguardano invece le parti civili istituzionali: Governo, Regione e Comune.
IL GOVERNO
Un Tribunale (anche in questo processo bis) potrebbe (finalmente) condannare Solvay a risarcire allo Stato i miliardi di euro di reiterati danni ambientali e sanitari inferti al territorio, ovvero la bonifica. Invece, con un patteggiamento che dà un colpo di spugna al processo, altro che enormità miliardarie: Solvay se la può cavare simbolicamente con un “dono” di poche centinaia di milioni. E continuare a produrre indisturbata: perché – è inteso – nel frattempo questo Governo, con la sua maggioranza, è ancor meno indicato dei precedenti a varare una legge che metta al bando i Pfas in Italia e dunque Solvay di Spinetta, che è l’unica che li produce. In Parlamento la lobby dei Pfas è onnipotente.
LA REGIONE PIEMONTE
Strozzando il processo, il patteggiamento serve a Solvay per evitare condanne miliardarie per danni di risanamento ambientale, cioè per bonifiche, e di costi sociali che la collettività è stata costretta (e sarà) a provvedere, cioè i costi delle strutture sanitarie per accertare e assistere i malati (e i morti). Solvay, con la trattativa in corso con la Regione Piemonte, conta di cavarsela con poche centinaia di milioni.
La Regione, in cambio del placet alla Procura, intende scrollarsi di dosso la pressione mediatica di Comitati e Associazioni che l’accusano da tempo immemorabile di omettere indagini ambientali e sanitarie. La Regione giustificherà il “dono” della Solvay proprio per il suo utilizzo a realizzare un monitoraggio della popolazione. La Solvay è tranquilla perché -è inteso – il biomonitoraggio non sarà di massa, cioè né riferito all’intera provincia, né all’intera zona della Fraschetta, né all’intero comune di Alessandria. Insomma, ai prelievi del sangue non avranno diritto decine di migliaia di persone. La “zona rossa” sarà abilmente circoscritta: ieri a “29 residenti o lavoratori agricoli”, oggi a “135 maggiorenni residenti entro 500 metri dal polo chimico di Spinetta Marengo”, domani “estesa” a qualche altra decina di persone, dopodomani a qualche altra, dopodomani…; non ci sarà mai un domani prossimo e certo per cui si possa parlare di monitoraggio di massa.
La Solvay è tranquilla. Il micro monitoraggio del sangue, e non anche delle urine, è ulteriormente limitato ai Pfas e non alla ventina di sostanze ancor più inquinanti (es. cromo esavalente), e neppure sarà refertato a tutti i Pfas, esclusi furbescamente proprio “i nuovi” (es. cC6O4 e ADV) che Solvay ora sta utilizzando. La Solvay è tranquilla: non ammetterà mai che il micro monitoraggio abbia valore probatorio, neppure indiziario, ben lungi da una indagine epidemiologica che le dimostri il nesso causa-effetto, meno che mai disposta a risarcire le vittime ammalate e morte.
Il compito affidato all’assessore regionale alla Sanità, Federico Riboldi, autorevole esponente nazionale di Fratelli d’Italia, è quello di andare in giro per Alessandria, assecondato ovviamente dagli omologhi comunale e provinciale, a propagandare il biomonitoraggio rallentato e disinnescato, e pomposamente ovvero ridicolmente definito “task force”, ad offuscarne e minimizzarne via via i risultati, insomma a fare da imbonitore presso quei Comitati che si prestino al gioco, a insultare invece quelli che hanno definito “omertoso” il suo operato. Si vergogni lui piuttosto, che vende la salute della popolazione.
IL COMUNE DI ALESSANDRIA
Il sindaco è la massima autorità sanitaria sul territorio, e dunque il sindaco di Alessandria con una ordinanza sarebbe stato in grado di fermare le produzioni inquinanti della Solvay di Spinetta Marengo e salvaguardare la salute dei concittadini. Si sa perché non lo farà mai, palleggiandosi dietro la Regione e il Governo. Ad evitare il ripetersi di pubbliche accuse, perciò, un patteggiamento gli sarebbe di sollievo. Anche perché stiamo parlando di soldi e il Comune non è che navighi in floride acque.
E c’è anche un’altra faccenda, che è stata accusata di mancanza di trasparenza dall’opposizione in Consiglio comunale. La Giunta ha autorizzato l’acquisizione di un’area nella zona dell’ex zuccherificio, tra Alessandria e Spinetta, circa 20mila metri quadrati (quasi tre campi da calcio), del valore fiscale di simbolici 34mila euro. Se a caval donato (“generosamente” dalla società Valtidone) si guarda in bocca, la dentatura è marcia perché il sottosuolo dell’ex zuccherificio è impregnato all’inverosimile dei veleni (cromo esavalente ecc.) della Solvay. Perché mai la Giunta ha acquisito un’area disastrata che il Comune non ha assolutamente i soldi per bonificare? Addirittura “per farne un centro studi dedicato alla bonifica ambientale” dice il sindaco Giorgio Abonante? E i soldi dove li trova per “realizzare una nuova strada per collegare il futuro secondo ponte sul fiume Bormida”? A pensare male si fa peccato, ma il pensiero va alla trattativa con Solvay. Sono tante le maniere per vendere la salute della gente.
Il programma di “Ammaliamo il mondo. La salute al primo posto?”
Clicca sul titolo per leggere il programma. Importante la discussione sui PFAS e su Spinetta Marengo.
Quindici le candidature al Premio Attila 2024. Votate
Dopo quelle già pubblicate, Meloni, Tajani, Sangiuliano, Toti, Craxi, Mattarella, Zelens’kyj, Battistini, Vittorio Emanuele, Vannacci, sono pervenute ulteriori candidature: clicca sul titolo.
L’intera Rassegna dei Premi Attila dal 2004 (pagine 125) è disponibile a chi ne fa richiesta.
È in corso un colpo di stato internazionale!
Clicca sul titolo per aderire al documento di “Perugiassisi per la cultura della pace”, “Unesco”, “Università degli studi di Padova”, “Centro di Ateneo per diritti umani Antonio Papisca”.
Le infinite vie della privatizzazione della sanità
Il CNEL nella Relazione 2024 sui servizi pubblici: sono 4,5 milioni le persone che nel nostro Paese hanno rinunciato a curarsi per problemi economici, lunghe liste d’attesa o difficoltà a raggiungere i luoghi di erogazione del servizio. Si tratta del 7,6% della popolazione italiana, in netto aumento rispetto agli anni pre-pandemia (6,3% nel 2019). La spesa pubblica in sanità continua ad essere una delle più basse in Europa (75,6% rispetto alla media europea) e comporta il contraltare di una spesa privata per le persone che ha superato i 40 miliardi. Il definanziamento del pubblico costituisce una spinta potentissima alla privatizzazione, che ha ormai raggiunto il 27,1% dell’insieme delle attività di ricovero. Clicca qui Marco Bersani.
Picco del 300% di aborti spontanei
Un rapporto accusatorio pubblicato dalla ong Human Rights Watch (HRW) rivela il catastrofico impatto dell’offensiva militare israeliana sulle donne incinte e sui neonati a Gaza, documentando gravi carenze di cure mediche, allarmanti incrementi di aborti spontanei e condizioni devastanti per i parti. Clicca qui.
La segregazione nelle RSA non è un fatto isolato
Non è riconducibile ad un luogo specifico ma ad una logica. Clicca qui Violenze e soprusi nelle RSA: non un fatto eccezionale, ma sistemico.
C’era una volta il medico di famiglia
I Pronto soccorso scoppiano. Le liste di attesa hanno tempi biblici. La sanità a pagamento va a gonfie vele. I Medici di medicina generale (Mmg) operano in convenzione col Servizio sanitario nazionale (Ssn) e la loro retribuzione si basa sul numero di assistiti. L’annunciata proposta del ministro Schillaci di trasformare i Mmg in dipendenti del Ssn è stata rigettata, anche per la stessa resistenza del sindacato maggioritario dei Mmg. È in corso un dibattito fra chi difende gli interessi corporativi e chi intende garantire un futuro al nostro Ssn che deve rimanere pubblico e universale. Clicca qui l’intervento di Mariolina Castelloni, vicepresidente del Senato.
La follia storica di equiparare svastica e falce martello
La risoluzione del Parlamento europeo approvata qualche tempo fa a Strasburgo, che chiede di vietare all’interno dell’Unione i simboli nazisti e comunisti sovietici, rende chiaro il balzo all’indietro, culturale e politico, dell’intera Europa.
“La falce e il martello”. Un simbolo che non era, e non sarà in seguito, solo dell’Urss né tantomeno solo di Stalin: piuttosto, nato e cresciuto dall’Ottocento fino a oggi, nel corso di grandi battaglie di progresso, di giustizia, di libertà.
La svastica hitleriana. Fu solo del dittatore tedesco e che accompagnò esclusivamente una dittatura violenta e folle, una guerra di aggressione e di conquista, l’annientamento ovunque fosse del popolo ebraico, lo scrigno di cultura, scienza e arte più prezioso in occidente.
Equiparare questi due simboli non è solo un’idiozia politica, un revisionismo spinto dalle temperie malefiche dell’oggi, piuttosto è una dimostrazione d’ignoranza e falsificazione totale della storia. Anzi, è la cancellazione della storia in sé. Clicca qui Goffredo Bettini.
Salvini: tranquilli, noi andiamo avanti
Una forte scossa di terremoto di magnitudo 4.8 è stata registrata nelle isole Eolie, in provincia di Messina. Lo ha rilevato l’Istituto nazionale di Geofisica e Vulcanologia. L’epicentro è stato individuato non lontano dall’isola di Alicudi, a 17 chilometri di profondità. La scossa è stata avvertita distintamente in altre province della Sicilia e anche a Palermo.
Salvini garantisce, dall’alto delle sue competenze ferroviarie, che al Ponte sullo Stretto non farebbe un baffo neppure una scossa di magnitudo 7,1 come quello che nel 1908 distrusse Messina e Reggio Calabria, neppure di magnitudo 12 e perfino oltre, neppure se accompagnata da maremoto o dalla caduta del governo Meloni.
L’inquinamento atmosferico è un’emergenza sanitaria
Nel mondo e in Italia. Necessarie misure urgenti per la tutela della salute pubblica. Secondo l’Organizzazione Mondiale della Sanità (OMS), ogni anno nel mondo circa 8,1 milioni di… Continua
Clicca qui Rete Italiana Pace e Disarmo.
Campagna per l’embargo militare contro il governo israeliano
Nonostante il cessate il fuoco, il governo di Tel Aviv non ha deposto le armi e dopo la Striscia di Gaza sta ora cercando di liquidare il problema palestinese in Cisgiordania; anche se il mondo continua, colpevolmente, a girare la testa dall’altra parte, la società civile continua a mobilitarsi in sostegno della causa palestinese.
PARTECIPANO BDS ITALIA – ASSOPACE PALESTINA – PAX CHRISTI – UN PONTE PER – PONTI NON MURI. Clicca qui.
550.000 persone con epilessia costrette alla clandestinità
La clandestinità a cui sono costrette 550.000 persone con le loro famiglie è il frutto della mancanza di una legge che dia loro piena cittadinanza. Lo denuncia l’AICE, nell’imminenza della Giornata Internazionale dell’Epilessia del 10 febbraio. Clicca sul titolo. Arrivi finalmente la Legge che dia piena cittadinanza alle persone con epilessia!
Si chiama così il documento nato dall’esperienza clinica maturata negli anni e dalle testimonianze raccolte dal Centro d’Ascolto di AISLA (Associazione Italiana Sclerosi Laterale Amiotrofica), e che sarà presentato durante un incontro online organizzato per il prossimo 14 febbraio. Clicca qui “Sessualità e SLA”: un tema da esplorare insieme.
_________________________________________________
contenuti 4 febbraio 2025
Pfas l’emergenza ecosanitaria dalle Alpi all’Etna
La spedizione “Acque senza Veleni” di Greenpeace ha avuto luogo tra settembre e ottobre 2024 per verificare la contaminazione da Pfas nell’acqua potabile in tutte le regioni d’Italia: sostanze tossiche e cancerogene secondo tutti gli studi scientifici internazionali, usate in numerosissimi processi industriali e prodotti di largo consumo, che si accumulano “inquinanti eterni” nell’ambiente e nel sangue provocando danni irreversibili alla salute umana. Per affrontare questa che per milioni di italiani è la forma di inquinamento più pericolosa che sta colpendo il nostro Paese, non vi è altra soluzione che la chiusura delle produzioni Pfas della Solvay di Spinetta Marengo (Alessandria) e il varo di una legge che vieti l’uso di tutti i PFAS in Italia.
Per realizzare la prima mappa nazionale indipendente, Greenpeace ha raccolto 260 campioni, soprattutto in fontane pubbliche, in 235 comuni appartenenti a tutte le Regioni italiane. I PFAS sono presenti nel 79% dei campioni di acqua potabile analizzati. Il cancerogeno PFOA è risultato il più diffuso. Consultando il report completo con tutti i risultati delle analisi PFAS, si tratta di una delle peggiori situazioni d’Europa.
Sull’indagine Greenpeace, clicca qui anche una vasta rassegna stampa (Scienze, Il Fatto alimentare, Repubblica, Fanpage, Corriere della sera, La Stampa, Radiogold, Resto del Carlino, Il manifesto, Avvenire, La nazione, Il fatto quotidiano,…), che comprende Piemonte, Veneto, Puglia, Liguria, Abruzzo, Emilia Romagna, Toscana, ecc.
Per una storia completa dei Pfas in Italia dal 1980, invece consulta gli oltre mille articoli sul sito www.rete-ambientalista.it o chiedici i tre volumi del dossier “Pfas. Basta!”.
Il 29 gennaio, la facciata metallica dell’edificio Berlaymont, sede della Commissione Europea, tra le bandiere europee, è stata illuminata da un messaggio in lettere bianche e gialle accompagnato da un teschio: “Bando ai PFAS adesso!”. Il clamoroso messaggio ha fatto seguito… allo scarico di secchi di terra contaminata davanti al cancello di Chemours a Dordrecht (Paesi Bassi), all’aver distribuito birre contaminate da PFAS agli operai di una fabbrica chimica a Zwijndrecht (Belgio) ed essersi accampati davanti al tribunale durante il processo Miteni a Vicenza (Italia).
Dietro questo appello all’esecutivo europeo, con richiesta di incontro con Ursula von der Leyen, presidente della Commissione, ci sono due organizzazioni ambientaliste, European Environmental Bureau e WeMove Europe, alle quali hanno aderito rappresentanti delle popolazioni belga, olandese, francese e italiana colpite dall’inquinamento da PFAS. In un’indagine in quattro episodi pubblicata dal 14 al 17 gennaio 2025 dalla RTBF e dai suoi 28 partner del progetto Forever Lobbying, hanno rivelato il costo colossale del disinquinamento dei PFAS in Europa: tra 95 miliardi di euro e più di 2.000 miliardi di euro in Europa nel corso di 20 anni, a seconda dello scenario. Oppure 100 miliardi di euro all’anno “in perpetuo”. Insomma, fermare ora la produzione di Pfas, in Italia fermare Solvay, sarebbe la soluzione più conveniente.
Questa indagine ha anche messo in luce un’attività di lobbying su scala senza precedenti da parte dell’industria chimica, fino ai vertici dell’esecutivo europeo, per ostacolare un piano di messa al bando degli “inquinanti eterni”.
In Italia, il Movimento di lotta per la salute Maccacaro ha denunciato (https://www.rete- ambientalista.it/2025/01/18/2- 000-miliardi-di-danni-la- lobby-dei-pfas-e-linciucione- italiano/) che la lobby delle aziende chimiche e industriali capitanata da Solvay è tutt’altro che rassegnata: grandi manovre sono in corso attorno ai processi Miteni di Vicenza e Solvay di Alessandria, con il sospetto che si voglia spegnerli, o quanto meno impacchettarli.
In Veneto (https://www.rete- ambientalista.it/2025/01/11/ delitto-perfetto-2-vicenza/) l’allarmato documento di Mamme No Pfas, Isde, Cillsa, Legambiente, Cgil Veneto e Rete dei comitati denuncia l’esistenza di un semiclandestino tavolo di autorità politiche, istituzionali e giudiziarie che tratta con le aziende imputate coprendone le responsabilità penali e risarcitorie.
In Piemonte è in corso l’altro “inciucio” della tabula rasa dei patteggiamenti giudiziali a danno delle Vittime e della bonifica (https://www.rete- ambientalista.it/2025/01/11/ delitto-perfetto-2- alessandria/).
L’ecomafia: la responsabilità di un’intera classe politica bipartisan
La Corte europea dei diritti umani (Cedu) condanna l’Italia per aver messo a rischio la vita degli abitanti della Terra dei Fuochi, dove oggi vivono 2,9 milioni di persone e dove gli scarichi illeciti di rifiuti pericolosi e le morti non sono un capitolo chiuso, qui, dove la criminalità organizzata ha gestito il traffico di rifiuti provenienti da ogni parte d’Italia, dalle concerie ai petrolchimici, fino alle industrie di alluminio, distruggendo la fertilissima Campania Felix, della quale non è rimasto più nulla.
Nella vasta area della regione Campania, tra Caserta e Napoli, compromessa dagli interramenti e dalle sostanze tossiche, le bonifiche vanno a rilento e c’è chi ancora aspetta i risultati dello studio Spes, un biomonitoraggio sulla popolazione residente promosso nel giugno 2016 da Istituto Zooprofilattico Sperimentale del Mezzogiorno e Istituto Pascale. Spesa: 30 milioni di euro.
La Cedu ha stabilito che il governo dovrà introdurre, senza indugio, misure generali in grado di affrontare in modo adeguato il fenomeno dell’inquinamento della Terra dei Fuochi. Significa che l’Italia ha due anni di tempo per sviluppare una strategia correttiva, mettere in piedi un sistema di monitoraggio che sia indipendente e una piattaforma di informazione pubblica.
Le campagne intorno ad Acerra sono uno dei Sin (siti di interesse nazionale) più vasti e densamente popolati d’Italia, con 80 comuni coinvolti e 1,8 milioni di persone che vivono nell’area. Qui le bonifiche sono solo agli inizi, mentre i roghi continuano. E i cittadini continuano ad ammalarsi.
E dal 2009 è entrato in funzione il più grande inceneritore d’Italia, un impianto per i rifiuti urbani che incenerisce 111 chili pro capite all’anno di rifiuti, quanto incenerisce la Lombardia in 13 impianti e altrettanti territori”.
Alla sentenza del Cedu si è arrivati attraverso 41 istanze collettive presentate nel 2015 da più di 3.500 persone e da cinque organizzazioni con sede in Campania. Molte di queste persone hanno visto morire figli, fratelli, nipoti, si sono ammalati. Nell’area interessata, infatti, insieme all’inquinamento delle falde acquifere, saliva anche il numero dei casi di cancro.
Per Legambiente, la sentenza della Cedu richiama alla responsabilità un’intera classe politica bipartisan “che per anni ha sottovalutato, nascosto quello che accadeva in quel territorio”. Legambiente ha coniato il termine Ecomafia per il suo rapporto, raccogliendo le denunce che arrivavano dai circoli presenti sul territorio. “Si sono succeduti 12 governi nazionali e 5 a livello regionale senza trovare un ‘vaccino’ efficace.
Le candidature al Premio Attila 2024
Stanno pervenendo le prime candidature per votare il Premio “ai nostri figli peggiori, alle personalità che si sono particolarmente distinte a danno dell’ambiente, della salute, della pace”. Le votazioni si concluderanno tradizionalmente il 28 febbraio. Dunque votate, con tanto di commenti: che verranno pubblicati.
Queste le candidature sopraggiunte:
Giorgia Meloni. Si vanta di essere una delle sette meraviglie del mondo (di cui tre italiane, con Mussolini e Berlusconi) per avere di nuovo riportato l’Italia al suo “posto al sole” nel mondo.
Antonio Tajani. Eterno secondo. Negli anni settanta fu vicesegretario del Fronte Monarchico Giovanile, ala junior dell’Unione Monarchica Italiana, la formazione politica vicina al ramo dei duchi di Aosta della famiglia di Savoia. Come già Vittorio Emanuele III, anche lui si esprime con comprensione nei confronti del Duce. All’ultimo convegno dell’Unione Monarchica Italiana: «Mussolini? Fino a quando non ha dichiarato guerra al mondo intero seguendo Hitler, fino a quando non s’è fatto promotore delle leggi razziali, a parte la vicenda drammatica di Matteotti, ha fatto delle cose positive per realizzare infrastrutture nel nostro Paese, poi le bonifiche».
Gennaro Sangiuliano. Oculatamente scelto quale titolare del Mi(ni)stero della Cultura che ha fatto in tempo a insegnare che “Cristoforo Colombo non ipotizzava di scoprire un nuovo continente, ma voleva raggiungere le Indie circumnavigando la terra sulla base delle teorie di Galileo Galilei”.
Giovanni Toti. Anche da Re Sole della Liguria, Giovanni Toti, detto l’Ammorbidente, non ha mai perso la faccia da scolaro con il grembiule bianco e il fiocco blu, seduto al primo banco nella classe che fu di Silvio Berlusconi, il mentore della sua vita, che tra una barzelletta e l’altra, tra una pupa in tacchi a spillo e uno scandalo ad personam, insegnava la grammatica del potere, l’apoteosi pubblicitaria del consenso, gli oscuri traffici di denari e altre utilità, che i teorici d’alta politica contemporanea chiamano “sangue e merda”, indispensabili ingredienti a confezionare pasti caldi per il pregiato pubblico degli elettori.
Bettino Craxi. Che era esule e non fuggito contumace, celebrato anche da Mattarella: “Le riforme di Craxi cambiarono l’Italia. Ha lasciato un grande segno nel Paese”.
Sergio Mattarella. Già vicepremier del governo che bombardò la Jugoslavia, mentre migliaia di magistrati con la Costituzione in mano uscivano dalle aule dell’anno giudiziario quando parlavano i rappresentanti dello sgoverno, più di tante parole ha colpito il suo silenzio: di garante supremo della Costituzione e dunque anche del potere giudiziario. Ma forse è meglio così: l’ultima volta che ha aperto bocca è stato per elogiare un ex premier pregiudicato per corruzione e finanziamento illecito che, dopo aver vilipeso la Giustizia del suo Paese, vi si era sottratto dandosi alla latitanza. Non resta che rimpiangere Pertini.
Volodymyr Zelens’kyj. Il tragico comico. Da anni dava del servo di Putin a chiunque gli chiedeva di negoziare con la Russia, e insultava chiunque gli capitasse a tiro, dal Papa all’Onu alla Croce Rossa; tipo: “Il Papa non può mediare, non è credibile, non capisce la politica: è filorusso”. Ora che la guerra è persa,vorrebbe che lo zar russo negoziasse con lui perché, proprio perché privo di legittimazione istituzionale, alla pari sente sé come lo zar ucraino.
Stefania Battistini. “Sono davvero onorata come giornalista del servizio pubblico di ricevere l’onorificenza dell’Ordine della Principessa Olga III grado, che il presidente Zelensky ha voluto attribuirmi come inviato di guerra. Un riconoscimento importante per il lavoro che il Tg1 e la Rai tutta hanno svolto in questi mesi per coprire sul campo gli effetti dell’invasione russa in Ucraina”.
Vittorio Emanuele. È morto a Ginevra a 87 anni. Le esequie nella basilica di Superga. Suo nonno Vittorio Emanuele III mise il Paese nelle mani di un dittatore, lo spedì in guerre coloniali feroci, accettò l’alleanza con il nazismo, firmò leggi razziste e antisemite, lasciò portar via migliaia di cittadini italiani ebrei, abbandonò centinaia di migliaia di soldati nelle mani dei nazisti e infine scappò con ignominia. Anche Vittorio Emanuele, nel suo piccolo, ha generato tragedie: da ubriaco un suo colpo di fucile tolse la vita a giovane tedesco. Ma con lui la dinastia è soprattutto passata dalla tragedia alla farsa: dentro la storia invisibile e sotterranea, legata a lobby riservate, logge segrete, loggia P2, aristocrazie occulte impegnate in affari internazionali, spesso sul crinale tra legalità e illegalità, sempre ricco sfigato, anche come mercante d’armi.
Roberto Vannacci. Pier Luigi Bersani è stato condannato con un decreto penale per diffamazione aggravata nei confronti di Vannacci, allora generale dell’esercito e ora eurodeputato della Lega. L’ex segretario del Pd, durante un dibattito alla Festa dell’Unità commentò il libro dell’ufficiale ‘Il mondo al contrario’: “Quando leggi quelle robe lì pensi: ‘Va bene dài, sciogliamo l’esercito, sciogliamo le istituzioni e facciamo un grandissimo bar’. Il Bar Italia. Dove puoi dare dell’invertito a un omosessuale, dove puoi dare della fattucchiera a una femminista, dove puoi dare del negro a un nero, dove puoi dire a un ebreo ‘ok la Shoah, ma non esageriamo’. Quel bar lì non sarebbe mai vuoto in Italia. Ma scusate, se in quel bar lì lui puoi dire tutte queste cose, è possibile dare del coglione a un generale?”.
L’intera Rassegna dei Premi Attila dal 2004 (pagine 125) è disponibile a chi ne fa richiesta a movimentodilottaperlasalute@reteambientalista.it
_________________________________________________
contenuti 28 gennaio 2025
Solo allora potrete dimenticarci
«Non comprendo, non sopporto che si giudichi un uomo non per quello che è, ma per il gruppo a cui gli accade di appartenere» scrisse Primo Levi. E tutta la vita ci avrebbe messi in guardia: «Al termine della catena c’è sempre il Lager, l’annientamento, lo sterminio. Così è, la storia dell’umanità.»
Quella vergogna oggi ancora esiste, ed è anzi persino più funerea: perché c’è stata Auschwitz nel cuore della “nostra” Europa e perché da allora si è detto, prima timidamente, poi convintamente e poi addirittura istituzionalmente: «Mai più». Ma gli ottant’anni trascorsi da allora, con l’elenco interminabile di orrori che va da Hiroshima all’Algeria, dal Vietnam al Ruanda, dalla Jugoslavia all’Afghanistan, dalla Siria a Gaza, sembrano dirci, con Levi, che siamo ancora lì, e che la nostra volontà, che sia «buona», «nulla» o «scarsa», «non abbia valso a difesa».
La prima pattuglia russa giunse in vista del campo verso mezzogiorno del 27 gennaio 1945, dell’ultimo giorno di Auschwitz, sabato, quello destinato verificarne e a celebrarne la “liberazione”, e quindi la spettacolosa fine del regno della morte voluto, programmato e costruito dal nazismo al centro dell’Europa. Nel KZ Auschwitz, Konzentrationslager Auschwitz, aveva trovato la morte per opera dei nazisti, a partire dal giugno 1940, un numero imprecisato di esseri umani, forse un milione e centomila, probabilmente un milione e trecentomila: uomini e donne, in grande maggioranza ebrei (più di un milione di vittime), rom e sinti, sovietici di varie nazionalità, oppositori politici, cittadini polacchi, omosessuali, anziani e bambini. I rom, al pari degli ebrei (e dei sinti), testimoniavano un’antica e radicata passione omicida del nazismo. (Continua cliccando sul titolo)
Il sistema di deportazione è stato inaugurato da Meloni e Edi Rama nel 2023 con un accordo fra l’Italia e la sua ex colonia Albania. Sono realizzati due centri in territorio albanese a spese italiane, dove i migranti catturati in mare a 500 Km di distanza vengono deportati: dapprima nel porto di Shёngjin e poi nella vicina cittadina di Gjadёr configurata come un Cpr (Centro di permanenza per i rimpatri) volto a detenere in carcere i migranti in attesa di essere respinti nei Paesi di origine. Il tutto è una violazione della Convenzione di Ginevra e delle Convenzioni internazionali di diritto del mare: ultimo anello di una catena che, imprigionando le persone migranti in una speranza negata, è lo specchio perfetto delle politiche italiane ed europee in materia di flussi migratori. Un modello, sì, ma di disumanità.
Sfogliate il libro delle nefandezze umane.
Alla pagina dell’anno 1619, mese di agosto, troverete l’immagine di schiavi denudati e incatenati in fila per entrare nella stiva della nave Sao Joao Baptista e poi della White Lion, i bastimenti negrieri che dalle spiagge dell’Angola portavano i primi 33 schiavi a Jamestown, Virginia.
Quello era il viaggio di andata.
E ora confrontate quella immagine, dipinta 406 anni fa, con la fotografia rilasciata dalla Casa Bianca del 47° presidente Donald Trump, intitolata “Deportazione!”, dove la scena è clamorosamente capovolta, ci sono una trentina di disgraziati in fila indiana e in catene, come si addice agli schiavi, che stanno salendo dentro la stiva dell’aereo da trasporto militare per essere espulsi, buttati via, come si fa con gli avanzi di un pranzo durato 4 secoli. Uomini in divisa e armati di fucile mitragliatore controllano la partenza degli schiavi rinominati “clandestini”, proprio come quattro secoli fa i trafficanti bianchi, armati di mazze e spade controllavano gli arrivi dei “selvaggi” appena razziati dai villaggi africani. Dopo quei 33 schiavi in America ne sono arrivati tra i 9 e i 15 milioni, nessuno è in grado di conteggiare uomini e donne che valevano qualcosa in vita e nulla da morti. Hanno lavorato nei campi prima della canna da zucchero poi in quelli di cotone a costo zero, se si esclude il cibo per il sostentamento delle braccia. Generando una formidabile ricchezza nell’America dei pellegrini bianchi che di genocidio in genocidio, sgomberarono le terre dell’oro e della frontiera. Fino a decollare verso i fasti economici della Rivoluzione industriale proprio come i cugini dell’impero britannico che prelevavano schiavi dall’Africa all’Oriente. L’abbiamo chiamato progresso, ce ne vantiamo, convinti come siamo che la crudeltà servita ieri e rinnovata oggi, resterà per sempre nel conto dei debiti sospesi.
Pino Corrias
Modello Israele. Si immagini ora un uomo a cui, insieme con le persone amate, vengano tolti la sua casa, le sue abitudini, i suoi abiti, tutto infine, letteralmente tutto quanto possiede: sarà un uomo vuoto, ridotto a sofferenza e bisogno, dimentico di dignità e discernimento, poiché accade facilmente, a chi ha perso tutto, di perdere se stesso; tale quindi, che si potrà a cuor leggero decidere della sua vita o morte al di fuori di ogni senso di affinità umana; nel caso più fortunato, in base ad un puro giudizio di utilità. Si comprenderà allora il duplice significato del termine “Campo di annientamento”…
Clicca qui Primo Levi.
Milei: “Non mi sento solo, con me Trump, Musk, Meloni”
Modello Argentina. Clicca sul titolo.
Tra memoria e attualità: il mondo sanitario nel programma di eutanasia nazista
Emmi G., di soli 16 anni, fu una delle migliaia di vittime con disabilità durante il nazismo. Giudicata “schizofrenica”, venne sterilizzata e successivamente inviata a Meseritz-Obrawalde, dove venne uccisa il 7 dicembre 1942 con un’overdose di tranquillanti.
Per il Giorno della Memoria presentiamo un approfondimento dedicato alle figure del mondo sanitario che parteciparono al “Programma di eutanasia” in cui, tra il 1939 e il 1945, trovarono la morte circa 200.000 persone con disabilità o con disturbi psichici. «Crimini che bisogna continuare a studiare e a ricordare, per riconoscere, prevenire e contrastare il rischio del riemergere di logiche discriminatorie e delle loro pericolose ricadute umane…
Clicca qui Tra memoria e attualità: il mondo sanitario nel programma di eutanasia nazista
Ammaliamo il mondo. La salute al primo posto?
Il 22 e 23 febbraio 2025 si terrà il corso di formazione “AMMALIAMO IL MONDO – La salute al primo posto?” L’evento può essere seguito online in diretta live o vissuto in presenza, presso la Fabbrica delle “E” a Torino, in Corso Trapani 91/b. (Clicca sul titolo.) Interverranno relatori di indiscussa professionalità e competenza del mondo medico e scientifico, giornalisti e rappresentanti di organizzazioni da sempre in prima linea su queste tematiche: Legambiente, Sapereambiente, Libera, Gruppo Abele, ISDE Associazione Italiana Medici per l’Ambiente, Torino Respira, Premio Luisa Minazzi, Movimento di Lotta per la Salute G. Maccacaro.
Il programma di “Ammaliamo il mondo. La salute al primo posto?”
Clicca sul titolo per visionare il programma.
Pieno appoggio del PD all’invio di armi in Ucraina
Clicca sul titolo.
Al via le votazioni per il Premio Attila 2024
Nel 2005 “La Rete ambientalista, il coordinamento provinciale dei comitati e delle associazioni alessandrine”, istituì il “Premio Attila Alessandria 2004” da attribuirsi “alla personalità che a livello locale si è particolarmente distinta a danno dell’ambiente e della salute”. Le votazioni si celebrarono durante le ricorrenti assemblee popolari e tramite “gli oltre 500 indirizzi e-mail che compongono la nostra rete telematica” (scrivemmo orgogliosamente).
Oggi, a venti anni di distanza, ci rivolgiamo in Rete a oltre 42milapersone. Nel frattempo, il Premio ha assunto una dimensione nazionale, con (inopportuna) tendenza a passare i confini. Insomma, il Premio Attila è, nel suo genere, la più alta onorificenza italiana… dopo il Festival di Sanremo. Vincitori i nostri figli peggiori: industriali, politici, amministratori che nel corso dell’anno si sono particolarmente distinti a danno dell’ambiente, della salute e della pace. L’intera Rassegna dei Premi Attila è disponibile a chi ne fa richiesta.
Avviamo dunque le votazioni per il PREMIO ATTILA 2024 che si concluderanno tradizionalmente il 28 febbraio. Cominciate dunque a inviarci le candidature, possibilmente corredate dalla motivazioni (argute, probabilmente).
Tutta la storia di Spinetta Marengo raccontata in video da Lino Balza
Sul sito, le puntate 11 e 12. Ovvero la storia del movimento operaio alessandrino attraverso la lente di ingrandimento della fabbrica Montedison-Solvay, ovvero vista dal basso la storia italiana dell’ascesa e della caduta del Movimento operaio e dei Movimenti ecopacifisti.
_________________________________________________
contenuti 19 gennaio 2025
2.000 miliardi di danni. La lobby dei Pfas e l’inciucione italiano
Rispetto a quando per la prima volta (nel 1990) scrivemmo che lo stabilimento di Spinetta Marengo scaricava Pfas in Bormida. Rispetto a quando dai primi anni 2000 eravamo in pochi, se non i soli, a diffondere sui Pfas informazioni e documenti internazionali sempre più allarmanti, anche trasmettendoli – come Movimento di lotta per la salute Maccacaro – in forma di esposti (20) alla Procura di Alessandria. Ebbene, rispetto a quei tempi, fino a quelli odierni, per tutti i quali ci appuntiamo la medaglietta di indefessa costanza, ebbene oggi si può affermare che la tragedia Pfas primeggia quasi in tutti gli organi di informazione, merito anche negli ultimissimi anni dell’accelerata mediatica della campagna di Greenpeace in Italia http://bit.ly/3FAJ7H0. Meglio tardi che mai. Ma non ancora a sufficienza.
Infatti, a tutt’oggi, le produzioni dei cancerogeni e tossici Pfas della Solvay non sono state fermate ad Alessandria e l’uso dei Pfas non è stato messo al bando in Italia.
Lo stallo malmostoso è il segno che la lobby delle aziende chimiche e industriali capitanata da Solvay è tutt’altro che rassegnata: grandi manovre sono in corso attorno ai processi Miteni di Vicenza e Solvay di Alessandria, con il sospetto che si voglia spegnerli, quando meno impacchettarli. In Veneto l’allarmato documento di Mamme No Pfas, Isde, Cillsa, Legambiente, Cgil Veneto e Rete dei comitati denuncia l’esistenza di un semiclandestino tavolo di autorità politiche, istituzionali e giudiziarie che tratta con le aziende imputate coprendone le responsabilità penali e risarcitorie
https://www.rete- ambientalista.it/2025/01/11/ delitto-perfetto-2-vicenza/.
In Piemonte: l’altro “inciucio” della tabula rasa dei patteggiamenti giudiziali a danno delle vittime e della bonifica, su cui hanno preso posizione Legambiente e Movimento di lotta per la salute Maccacaro https://www.rete- ambientalista.it/2025/01/11/ delitto-perfetto-2- alessandria/.
A lato di questo “inciucione”, la lobby è quanto mai aggressiva in campagne di pressione sui politici e di disinformazione atte a sviare l’attenzione pubblica dalle loro responsabilità verso i rischi per la salute e i relativi costi sociali (esemplari furono le campagne pro-tabacco). Lo scopo delle centinaia di lobbisti (addirittura Mario Draghi) è duplice: indebolire e affossare la proposta di Bruxelles di vietare la vendita e commercializzazione dei Pfas, e spostare il peso economico dei lavori di bonifica dalle aziende ai cittadini.
La multinazionale belga in Europa mantiene, con Ilham Kadri amministratrice delegata di Syensqo spin off di Solvay, un ruolo apicale nella “Campagna di disinformazione” dopo la richiesta di restrizione e divieto dei Pfas promossa nel 2023 dai cinque Stati europei (Danimarca, Germania, Norvegia, Olanda, Svezia). La campagna punta all’esclusione dal divieto dei fluoro polimeri, da considerarsi innocui prodotti finiti rispetto ai Pfas “storici” intermedi di produzione, e soprattutto da affermarsi essenziali per lo sviluppo della nuova tecnologia verde sponsorizzata dal Green Deal e finanziata in parte dal PNRR. Il nuovo fluoropolimero essenziale per l’idrogeno verde sarebbe “Aquivion, che dal 2025 a Spinetta noi produrremo senza utilizzo di Pfas”. Falso. Aquivion rimane un Pfas e una volta riversato in ambiente il prodotto degrada in Pfas”: clicca qui.
Nella sua campagna, la lobby sta anche fronteggiando l’indagine interdisciplinare transfrontaliera coordinata da Le Monde, Forever Lobbying Project (FLP), che coinvolge 46 giornalisti di diverse redazioni, 18 esperti accademici e avvocati internazionali e 29 media partner in 16 Paesi.
L’indagine “sulla peggiore crisi di inquinamento che l’umanità abbia dovuto affrontare”, utilizzando una metodologia articolata e basata su criteri scientifici, ha infatti portato a galla quanto costerà ripulire dal “veleno del secolo” 23.000 siti in Europa, tra cui quelli, come Alessandria e Vicenza, considerati “hotspot PFAS”, dove la contaminazione ha già dimostrato di aver raggiunto livelli particolarmente pericolosi per la salute delle popolazioni esposte. A prescindere dagli incalcolabili costi umani e sociali in morti e ammalati e dall’impatto dei PFAS sui nostri sistemi sanitari, l’indagine si è “limitata” a calcolare i costi per bonificare le falde acquifere e i terreni impregnati di PFAS.
La cifra è da capogiro, ed equivale a 2 trilioni e mezzo di euro, 2,5mila miliardi di euro in un periodo di 20 anni, ovvero un costo annuale pari a 100 miliardi di euro. Per l’Italia, ad esempio, l’opera di pulizia costerebbe intorno a 12 miliardi di euro l’anno: stima assai per difetto se solo si guardano i costi depositati presso il tribunale di Vicenza. Cifre che comunque esploderebbero ulteriormente, in perpetuo, se non ci sarà lo stop immediato dei Pfas.
Il nodo politico è: questi costi da chi verranno affrontati? Dalle aziende che hanno messo in circolazione il PFAS, o dai cittadini tramite le proprie tasse?
Il principio sarebbe: chi inquina paga. Dunque il nodo è politico: mentre gli altri Paesi CEE chiedono a gran voce all’Agenzia Europea delle Sostanze Chimiche (ECHA) di mettere al bando i PFAS, in Italia la storica complicità politica e sindacale, delle istituzioni locali e governative, non ferma le produzioni Pfas della Solvay a Spinetta Marengo, primo indispensabile passo verso il divieto in Italia dell’uso di Pfas in tutte le manifatture, come fu (nel 1992) per l’Eternit e l’amianto.
Lino Balza, Movimento di lotta per la salute Maccacaro
Pfas anche nei cinturini degli smartwatch
Ormai l’elenco dei prodotti di largo consumo con Pfas è talmente lungo che, sintetizzando, si può dire che va dalla carta igienica, passando per le pentole antiaderenti, fino… ai cinturini degli orologi.
Nei cinturini degli smartwatch e fitness tracker a rilasciare più Pfas sulla nostra pelle sono proprio quelli di marche “premium”, di giganti come Apple, Nike, Fitbit (di proprietà di Google) e Samsung. Lo studio è opera di un team di ricerca dell’Università statunitense di Notre Dame, guidato dal professor Graham Peaslee, che ha analizzato 22 cinturini realizzati con materiali diversi, tra cui fluoro elastomeri (Pfas), plastica, pelle e metalli. Addirittura sono proprio i cinturini con un costo superiore a 30 dollari quelli che presentano livelli più elevati di fluoro, indicatore della presenza di Pfas, rispetto a quelli con un prezzo inferiore a 15 dollari.
Già gli studi precedenti, esempio dell’Istituto tedesco Bundesinstitut für Risikobewertung (BfR) per quanto riguarda cosmetici e creme solari, hanno dimostrato che i Pfas, non solo respirati e mangiati, sono anche assorbiti dalla pelle e perfino con presenza minima contaminano il sangue per anni.
Ne abbiamo più volte documentato, non è una novità (esempio in questo articolo). L’ennesima conferma arriva da un test effettuato dall’associazione ambientalista Pesticide Action Network Europe (PAN Europe) che ha portato in laboratorio 19 marchi di acqua minerale provenienti da diversi Paesi europei, trovando in più della metà di esse acido trifluoroacetico (TFA), una piccola molecola che fa parte della categoria degli PFAS.
Acqua con Pfas in rubinetto e bottiglie
Una nuova analisi, pubblicata in esclusiva dal Guardian, ha rivelato che le fonti d’acqua potabile in tutto il Regno Unito sono contaminate dai Pfas. Le più alte concentrazioni sono state rilevate in aree che ospitano grandi aree industriali (Ucelby e Barrow nel Lincolnshire) e vicino alle basi militari RAF (nel West Suffolk e nel Norfolk). Un rapporto dell’Environmental Agency ha dichiarato che potrebbero esserci fino a 10.000 siti contaminati: anche in Inghilterra le principali fonti di inquinamento sono le industrie chimiche, i siti militari, gli aeroporti, gli impianti di trattamento delle acque reflue, aziende produttrici di carta, pelle, tessuti e siti di smaltimento dei rifiuti, fanghi di depurazione sparsi su terreni ad uso agricolo. L’associazione di categoria Water UK chiede di “vietare i PFAS e sviluppare un piano nazionale per rimuoverli dall’ambiente, che dovrebbe essere pagato dai produttori”.
Prima conta del genocidio a Gaza
In attesa del futuro aggiornamento per malattie, fame, freddo, senza case, scuole, ospedali.
Clicca qui. Traumatici injury mortality in the #Gaza Strip from Oct 7, 2023, to June 30, 2024: a capture–recapture analysis – The Lancet
Clicca qui la traduzione italiana “Abbiamo stimato 64.260 decessi…
Violazioni dei diritti umani nella guerra in Ucraina
Il rapporto delle Nazioni Unite menzionato nell’articolo di InsideOver
https://it.insideover.com/ guerra/ucraina-e-russia-il- rapporto-onu-sulle-violazioni- del-diritto-non-risparmia- nessuno.html
evidenzia violazioni del diritto internazionale commesse sia dalla Russia che dall’Ucraina nel contesto del conflitto in corso. Secondo il rapporto, entrambe le parti sono responsabili di azioni che contravvengono alle norme internazionali, senza che nessuna delle due possa essere considerata esente da colpe.
In particolare, il rapporto documenta casi di maltrattamenti e torture subiti dai prigionieri di guerra di entrambe le nazionalità. Sono state condotte interviste con 174 prigionieri di guerra ucraini negli ultimi 18 mesi, e quasi tutti (169 su 174) hanno fornito resoconti di maltrattamenti durante la detenzione.
Queste violazioni includono trattamenti inumani e degradanti, che rappresentano una delle pagine più dolorose e meno espresse di questo conflitto.
Il rapporto sottolinea l’importanza di rispettare il diritto internazionale umanitario e i diritti umani, esortando entrambe le parti a cessare immediatamente tali pratiche e a garantire la protezione dei civili e dei prigionieri di guerra.
_________________________________________________
contenuti 12 gennaio 2025
Grandi manovre attorno ai processi di Vicenza e Alessandria, rispettivamente contro Miteni (Mitsubishi e Icig) e contro Solvay, con il sospetto che si voglia spegnerli, quando meno impacchettarli.
A Vicenza il processo Miteni, sulle responsabilità del maxi inquinamento da Pfas in Veneto, arriva alle ultime battute: a febbraio inizieranno la requisitoria del pubblico ministero e le arringhe delle parti civili e delle difese. Incombe sempre l’ombra della prescrizione.
In questo contesto si colloca l’allarmato documento dei comitati e delle associazioni ambientaliste del Veneto. L’esplosiva presa di posizione denuncia l’esistenza di “Un tavolo di autorità politiche, istituzionali e giudiziarie che si sta occupando in modo alquanto misterioso della trattativa con le società coinvolte nel processo per disastro ambientale e inquinamento di acque”. È più di un sospetto, in quanto precisano:
“Da un’audizione in Commissione parlamentare del procuratore Lino Giorgio Bruno è emersa l’esistenza di un tavolo, oltre quelli istituzionali, di cui non si conosce né la composizione, né i contenuti discussi, le priorità stabilite e i risultati conseguiti. Incontri promossi dal prefetto di Vicenza vedono la partecipazione dello stesso procuratore, di rappresentanti della Provincia, dei legali delle tre aziende imputate, nonché della Marzotto, la società che oltre quarant’anni fa diede vita alla Rimar, le cui ricerche portarono poi alla costituzione della Miteni, l’origine degli sversamenti chimici”.
L’accusa è precisa: “Riteniamo grave questo modo di agire connotato da poca trasparenza e scarsissima informazione”, che tende a coprire dodici anni di inefficienze e omissioni istituzionali, compresa la magistratura. L’opacità riguarda “lo stato della bonifica, sia per il terreno che per la falda”; fatto sta che “né la bonifica né la messa in sicurezza del sito sono cominciate”, mentre “non si ha notizia dell’avvio di un’indagine per omessa bonifica, che pur costituisce un reato gravemente punito dalla legge”.
Manca un aggiornamento da parte della Regione della mappa delle zone impattate, anche con campionamenti di terreni e degli alimenti. A loro volta, le indagini epidemiologiche sono ferme a uno studio di cinque anni fa e la mappa delle zone contaminate non viene aggiornata. Tant’è che “allo studio di mortalità nella popolazione veneta (4.000 decessi in più rispetto alla media di altre zone) non è stato dato seguito in termini di misure conseguenti”.
In definitiva, sarebbe un “inciucio”. “Dietro le quinte, un tavolo di autorità politiche, istituzionali e giudiziarie, senza trasparenza si sta occupando della trattativa con le società coinvolte, con l’effetto di avvolgere nel silenzio un disastro ambientale di portata epocale irrisolto”. Sapendo che “l’inquinamento continua inesorabilmente a scendere verso valle e a propagarsi, bioaccumulandosi in ambiente e negli organismi”. In più, sarebbe un “inciucione” se dietro le quinte, ci fosse lo zampino di Solvay, che ha tutto l’interesse di instaurare una “pax Pfas” in Italia.
Delitto Perfetto 2. Alessandria
Grandi manovre attorno ai processi di Vicenza e Alessandria; rispettivamente contro Miteni (Mitsubishi e Icig) e contro Solvay, con il sospetto che si voglia spegnerli, quanto meno impacchettarli.
Ad Alessandria, per il 2° processo Solvay, il nuovo staff legale della multinazionale sta cercando di strozzarlo “in nuce”. Ha proposto il “patteggiamento”, che ha provocato un ulteriore rinvio delle udienze di altri sei mesi. La mossa successiva potrà essere la richiesta premiale di “giudizio abbreviato”. Infine, è pronta la “rimessione alla sede” per incompatibilità ambientale (processo a Milano).
Andando per ordine. Circolante in sordina tra avvocati (come rivelammo alcuni mesi fa), oggi, dopo l’udienza dal GUP del 20 dicembre 2024, è ufficialmente avviato un patteggiamento (rectius) premiale da condursi con tavoli di trattative tra gli imputati e le parti civili. La Procura rinuncerebbe alla celebrazione del processo secondo gli iniziali capi di imputazione e relative pene e risarcimenti.
Il fine della multinazionale belga sarebbe di alleggerire ulteriormente i reati, ma soprattutto di prendersi in tranquillità il tempo necessario per la sua strategia post 2026. Soprattutto cioè di allentare il fiato sul collo da parte dell’opinione pubblica che addita Regione, Sindaco e Governo come complici di Solvay, e chiede biomonitoraggi di massa per la popolazione e addirittura ordinanze di chiusura degli impianti, nonché una legge nazionale di bando dei Pfas.
Non a caso gli avvocati di Comune, Regione e Governo sono entusiasti del “tavolo di trattative”. Non lo sono le Associazioni, tra cui quelle parti civili presenti al processo, 46 ONG e 40 scienziati che hanno appena firmato alla Commissione Europea per le restrizioni della produzione e dell’uso dei Pfas.
La “tabula rasa” dei patteggiamenti non passerebbe senza colpo ferire fra la popolazione alessandrina, tra le vittime malati e morti. Immediate le reazioni di Legambiente e Movimento di lotta per la salute Maccacaro. Patteggiare significherebbe impedire ai lavoratori e ai cittadini danneggiati di costituirsi parte lesa in sede civile e chiedere, almeno in quella sede, il risarcimento dei danni subìti invece che elemosine.
A prescindere da etica e morale, l’avallo di patteggiamento o rito abbreviato sarebbero giuridicamente una figuraccia clamorosa per la nuova Procura, dopo le critiche indirizzate alla vecchia che ha istruito i capi di imputazione sui reati di colpa piuttosto che di dolo.
Nessuno, infatti, può nascondersi dietro un dito. Il combinato disposto fra capo di imputazione colposo e patteggiamento chiarirebbe anche ai più miopi che questo processo, anche questo processo, non determinerebbe la bonifica del sito chimico di Spinetta Marengo. Il patteggiamento non può essere “venduto” come avvio di una vera bonifica. La “conditio sine qua non” per l’avvio di una vera bonifica è invece la chiusura delle produzioni inquinanti: non può esistere bonifica mentre si sta continuando a inquinare terra-acqua-aria. Per svuotare la vasca bisogna prima chiudere il rubinetto. Altrimenti va avanti eterna l’innocua manfrina del primo processo Solvay, anno 2009, per la quale ancora oggi sono in discussione con gli enti locali la “caratterizzazione del sito” e l’“analisi del rischio”, dell’irrisolto micidiale cromo esavalente (e altri 20 veleni tossico cancerogeni), mentre si è aggiunto il dilagare dei Pfas: appena la punta dell’iceberg di una realtà territoriale su cui incombe uno “stabilimento a rischio di incidente rilevante”, in pieno centro abitato, oltremodo più pericoloso del deposito Eni di Calenzano.
Mappa interattiva dei Pfas veneti
ll dott. Vincenzo Cordiano (ISDE Veneto), nel suo blog https://www.vincenzocordiano. i… ha pubblicato una mappa, da lui realizzata, sulla presenza di PFAS nelle acque del Veneto. La mappa interattiva consente di visualizzare le località nelle quali i tecnici dell’ARPA (Agenzia Regionale per la Protezione Ambientale) del Veneto hanno eseguito la ricerca delle Sostanze perfluoroalchiliche.
Luca Chiovato, ordinario di Endocrinologia all’Università di Pavia, membro di lungo corso della Società Italiana di Endocrinologia, della European Society of Endocrinology e la Endocrine Society Americana, è dal punto di vista scientifico uno dei più titolati a parlare di Pfas. È stato uno dei primissimi in Italia ad occuparsi dei Pfas distruttori endocrini, creando all’Irccs Maugeri di Pavia, un Laboratorio di ricerca dedicato già nei primi anni 2000.
In questa intervista
https://gognablog.sherpa- gate.com/lendocrinologo-come- i-pfas-ci-avvelenano/
Chiovato illustra come i Pfas operino sull’organismo dell’uomo come distruttori endocrino-metabolici.
Quale il grado di pericolosità?
Diminuzione della fertilità (riduzione numero spermatozoi), ipertensione arteriosa durante la gravidanza, neonati sottopeso, abbassamento della risposta anticorpale in adulti e bambini, innalzamento dei livelli di colesterolo, obesità, diabete tipo 2, dislipidemia, aumento dei rischi di malattie ad assi gonadici e alla tiroide, lesioni al fegato, colite ulcerosa, ipotiroidismo nei giovani (in gravidanza: conseguenze sullo sviluppo mentale dei neonati, malformazioni congenite, criptorchidismo (mancata discesa dei testicoli nel bambino), pubertà precoce. In particolare, le neoplasie: tumori ai reni e ai testicoli, tumori femminili ormono-dipendenti, come quelli di mammella e utero nelle donne, tumore alla tiroide (per anni oggetto di controversie, ma uno studio caso-controllo multicentrico Usa-Olanda-Israele, pubblicato nel 2023, ha stabilito il rapporto tra Pfos e carcinoma papillare della tiroide).
Nella stessa intervista, Chiovato sottolinea le caratteristiche di pericolosità dei Pfas: largamente utilizzati in tutti i prodotti industriali (dalle pentole antiaderenti alle carte igieniche) in quanto respingono sia acqua, sia grassi e resistono al calore, ma resistono alla degradazione chimica/microbica e hanno elevata solubilità in acqua, non sono biodegradabili quindi sono inquinanti organici persistenti, forever chemicals, la loro emitività, vale a dire il loro tempo di decadenza nell’ambiente è di 41-92 anni e l’emivita di eliminazione nell’uomo è di 3-7 anni.
Insomma, conviene il professore, siccome non ci sono antidoti per i Pfas, ce ne sarebbe abbastanza per metterli al bando come la Francia ha fatto. A maggior ragione perché le grandi compagni chimiche americane hanno “volontariamente” eliminato l’uso di Pfoa e Pfos nei primi anni 2000.
Il bisfenolo colpisce nell’anonimato
Già vietato nell’UE per i biberon (nel 2011!) e prodotti simili, la Commissione Europea ha adottato il divieto sull’uso del bisfenolo A (BPA) nei materiali che entrano a contatto con gli alimenti o bevande come il rivestimento su lattine di metallo, bottiglie di plastica riutilizzabili per bevande, refrigeratori per la distribuzione dell’acqua e altri utensili da cucina. Il divieto tiene conto dell’ultima valutazione scientifica dell’Autorità europea per la sicurezza alimentare (EFSA) dannosi sul sistemi immunitario riproduttivi ed endocrino. Clicca qui.
Nell’attualità del 2°processo Solvay in Alessandria, rimarchiamo le responsabilità dei mancati fattuali riscontri agli esposti (pec, a firma Lino Balza) a Procura-Prefetto-Arpa, a conferma di quanto avevamo denunciato: alla Solvay di Spinetta Marengo nel cocktail con i PFAS (PFOA, C6O4, ADV) tra gli interferenti endocrini c’è anche il bisfenolo nelle sostanze in uso.
Ci ricordiamo gli esposti alla Procura di Alessandria, dal 2009, del “Movimento di lotta per la salute Maccacaro”? Oltre ai Pfas in acque e aria, e nel sangue dei lavoratori! denunciavamo – sulla base degli allarmi internazionali – l’utilizzo nella Solvay di Spinetta Marengo anche del bisfenolo, tossico e cancerogeno. Di cui le autorità sanitarie, Arpa, Asl, e politiche, Comune, Provincia, nulla sapevano o fingevano di non sapere. Sta di fatto che nessuno è intervenuto ad Alessandria, neppure la magistratura.
“Operazione fiumi” condotta da Legambiente con il supporto tecnico di Arpav. Pfas anche nell’Adige. La presenza di Pfas era già emersa nel Po e il dito si è puntato sullo stabilimento piemontese della Solvay a Spinetta di Marengo. Una presenza di Pfoa confermata nelle acque campionate a Porto Tolle e Zevio.
Nel “Monitoraggio delle sostanze perfluoroalchiliche nelle acque superficiali del Veneto 2013 – 2018”, del resto, erano stati trovati anche nello scolo Poazzo, oltre che in Brenta, Fratta Gorzone, Bacchiglione, bacino scolante nella laguna di Venezia, Livenza, Po e Sile.
In Europa crescita di alta concentrazione di PFAS nell’acqua dolce, compresa l’acqua potabile
Sono state pubblicate sulla Gazzetta Ufficiale dell’Unione Europea le “Linee guida tecniche sui metodi d’analisi per il monitoraggio delle sostanze per- e polifluoro alchiliche (PFAS) nelle acque destinate al consumo umano”. Nel documento si legge che “si rileva in tutta l’UE la crescita del numero di casi di alta concentrazione di PFAS nell’acqua dolce, compresa l’acqua potabile”, per questo la Commissione, con queste nuove linee guida, vuole imprimere un’accelerazione al monitoraggio dei PFAS con criteri omogenei nell’ambito dell’Unione Europea, in base a quanto stabilito dalla direttiva (UE) 2020/2184, recepita in Italia con il D.Lgs. 23 febbraio 2023, n.18). Clicca qui.
Nuova allerta alimentare per un lotto di vongole del Pacifico surgelate. Il Ministero della Salute ha disposto il ritiro da un ipermercato di vongole sgusciate e surgelate: “Vongole del Pacifico sgusciate cotte surgelate” da 800 grammi del marchio Coralfish, importate da Panapesca Spa. Il nome del produttore è Ngoc Ha Co food processing and trading, con base in Vietnam. I supermercati dovrebbero aver provveduto a rimuovere dagli scaffali le confezioni.
L’esposizione ai PFAS dunque non avviene solamente nelle zone altamente contaminate, ma anche, magari attraverso imballaggi alimentari, mangiando frutta, verdura, carne e derivati e prodotti ittici. Su questi ultimi lo studio americano condotto nel New Hampshire tra i principali consumatori di frutti di mare degli Usa ha evidenziato come il consumo frequente di frutti di mare comporti una maggiore esposizione ai PFAS. Per quanto riguarda frutta e verdura, invece, è l’ONG PAN Europe a fare un quadro della situazione, tutt’altro che positivo: negli ultimi 10 anni, c’è stato un aumento del 220% delle tracce di forever chemicals in frutta e ortaggi dell’Ue. Altri studi hanno rilevato le sostanze per-e polifluoralchiliche anche in carne (soprattutto lavorata), uova, riso bianco e caffè.
Usare carta da forno solo se con l’etichetta “pfas free”
Alternative alle carte da forno sono i tappetini riutilizzabili in silicone alimentare che possono essere usati centinaia di volte, ma è importanza cruciale affidarsi ad aziende che espongono nelle confezioni i marchi sulla sicurezza alimentare. L’alternativa semplice è l’uso di grassi naturali (come l’olio d’oliva), oppure di foglie naturali, come quelle di banano, di vite o di cavolo. L’alternativa globale è chiudere le produzioni Pfas di Spinetta Marengo e vietare per legge l’uso e il consumo di tutti i prodotti contenenti Pfas. L’Associazione Italiana Medici per l’Ambiente (ISDE Italia) ha pubblicato un position paper che raccoglie ricerche e documenti che analizzano gli effetti sulla salute dei PFAS tossici e cancerogeni.
L’Italia cuoce nei Pfas a fuoco lento
Sono passati più di vent’anni da quando, già licenziato e riassunto di nuovo dal pretore, stavo facendo campagna in Italia contro l’uso delle ormai famose “padelle antiaderenti” ai cibi, antiaderenti grazie al miracoloso Teflon prodotto dalla Solvay di Spinetta Marengo (AL), azienda di cui ero dipendente. Eppure vedo ancora oggi esposte nei negozi padelle antiaderenti senza il marchio “Pfas free”, malgrado che nel frattempo la cancerogenicità del PFOA sia ormai scientificamente assodata e allertata. E malgrado che siano tranquillamente disponibili pentole e padelle in acciaio inox, ghisa, titanio, vetro e ceramica certificata. C’è da trasecolare, infine, a pensare in chissà quante cucine si stiano cuocendo Pfas a oltre 260 gradi addirittura in padelle consumate e graffiate. D’altronde nessuna legge vieta alla Solvay la produzione di Pfas “forever chemicals” e il suo uso in una infinità di prodotti agricoli, alimentari, industriali, chimici, farmaceutici, ecc.
Aggiornamenti di Gogna Blog sulla vicenda Pfas della Solvay di Spinetta Marengo. Clicca qui.
No al nuovo invio di armi italiane in Ucraina
Campagna: No al nuovo invio di armi italiane in Ucraina promossa da Alex Zanotelli e altre personalità (vedi elenco).
Chiediamo ai parlamentari italiani – ai sensi dell’articolo 50 della Costituzione Italiana – di formulare un atto di indirizzo contrario ad alimentare la guerra in Ucraina mediante l’ulteriore fornitura di armi e di rifiutare la conversione in legge del decreto 200/2024. Riteniamo che questo nuovo invio vada contro gli interessi stessi della popolazione ucraina, che in sempre maggior numero rifiuta di andare a combattere (800.000 renitenti alla leva, secondo la stima del presidente della commissione Affari economici del Parlamento ucraino, Dmytro Natalukha, riferito al quotidiano “Financial Time”).
I morti sul lavoro nell’intero 2024 a cura dell’Osservatorio di Bologna morti sul lavoro
Clicca qui il report a cura di Carlo Soricelli. Tutti i dati sono scandalosi, per le donne, gli stranieri, gli autotrasportatori ecc. Fra tutti, è incredibile la strage di anziani che muoiono lavorando: sono oltre il 30% degli ultrasessantenni e di questi sempre sui luoghi di lavoro 157 hanno addirittura più di 70 anni. È davvero incredibile non fare nessuna distinzione sull’età per andare in pensione tra chi svolge un lavoro pericoloso e chi no.
Anche a colpi di espropri illegittimi
ll movimento No-Tav denuncia l’illegittimità degli espropri avvenuti nel terreno di San Giuliano coinvolgendo attivisti ed eredi. «Le convocazioni di Nicoletta Dosio, per la quota eredita dal marito, e di altri eredi dei 1054 proprietari originari del terreno di San Giuliano dimostrano che il violento sgombero del presidio Sole e Baleno nell’ottobre scorso, e la conseguente occupazione da parte di Telt, sono avvenute in modo totalmente illegittimo, violando i diritti dei comproprietari» denuncia il movimento No Tav, che nella frazione alle porte di Susa ha dato vita ad una mobilitazione accanto all’area dove ad ottobre sono partite le procedure di esproprio per permettere di acquisire il terreno lungo la ferrovia Susa-Bussoleno, destinato ad accogliere parte del futuro cantiere per la costruzione della stazione internazionale della Torino-Lione.
Insieme a Nicoletta Dosio, anche altri eredi di alcuni dei 1054 proprietari dell’appezzamento acquistato collettivamente dagli attivisti nel 2012, in occasione della campagna “Compra un posto in prima fila” lanciata dal movimento ambientalista valsusino. «Io oggi non ho firmato nulla, come non l’avevo fatto a ottobre per la mia quota di proprietà, e non sono andata a constatare lo stato dei luoghi perché l’area del presidio è stata devastata in questi mesi, e c’è solo da constatare che dove un tempo c’erano orti e pascoli oggi resta solo un cumulo di ferraglia e asfalto» sottolinea Nicoletta Dosio, chiamata stavolta a cedere la proprietà della quota ereditata in seguito alla scomparsa del marito, Silvano Giai, lo scorso anno.
Nei prossimi mesi si passerà poi all’esproprio delle tre abitazioni che sorgono lì vicino, destinate all’abbattimento per far spazio ai cantieri della Torino-Lione: «L’ennesimo scempio in una Valle già devastata ai tempi della costruzione dell’autostrada» conclude il movimento No Tav, che ribadisce di «aver già denunciato, con due diversi esposti presentati in Procura nei mesi scorsi, l’illegittimità delle operazioni portate avanti in questi mesi nell’area un tempo occupata dal presidio Sole e Baleno».
Tutta la storia di Spinetta raccontata in video da Lino Balza. L’attualità del pensiero di Giulio Alfredo Maccacaro
Decima puntata
_________________________________________________
contenuti 4 gennaio 2025
Sempre migliori le notizie per i fabbricanti di armi in tutto il mondo. Nel 2024, le fabbriche per il terzo anno consecutivo, hanno marciato a pieno ritmo. Dal 2025, con Donald Trump, la corsa al riarmo sarà ancora più forsennata, specie in Europa. Trump vuole infatti che i paesi Nato aumentino la spesa militare al 5% del Pil. Per l’Italia, ferma all’1,5%, vorrebbe dire spendere 50 miliardi in più all’anno, rispetto a una spesa che per l’anno prossimo è fissata in 32,2 miliardi, un nuovo record peraltro. Ottime prospettive dunque anche per Fincantieri, Avio e Leonardo. Quest’ultima appena in undicesima posizione (clicca qui) nella classifica del settore che mostra che le cinque più grandi del mondo sono tutte statunitensi: Lockheed Martin, Rtx-Raytheon, Northrop Grumman, General Dynamics e Boeing. Per le famiglie, rincaro ovviamente per le tariffe energetiche, bollette luce e gas, code negli ospedali, calcinacci nelle scuole…
Lettera aperta di matematici contro il genocidio di Israele
I 1.078 firmatari denunciano il genocidio e chiedono di tagliare i ponti con le istituzioni israeliane che non lo condannano.
Il 7 ottobre 2023 Hamas ha compiuto un attacco terroristico in Israele, uccidendo più di 1.200 persone su una popolazione di 9,5 milioni, tra cui oltre 800 civili e almeno 33 minorenni, e ferendone altri 5.400. L’attacco ha portato anche alla cattura di 248 ostaggi, circa 100 dei quali ancora detenuti a Gaza. Da allora il governo israeliano ha lanciato una violenta risposta di genocidio contro la popolazione palestinese di Gaza, sotto gli occhi della comunità internazionale.
Alla fine di ottobre 2024 le vittime identificate avevano raggiunto quota 43.061, tra cui oltre 13.735 bambini, 7.216 donne e 3.447 anziani, con oltre 100.000 feriti, su una popolazione di 2,3 milioni. Migliaia di altre vittime rimangono disperse, sepolte sotto le macerie. L’esercito israeliano sta infliggendo ai civili palestinesi non meno che l’equivalente di un 7 ottobre ogni dieci giorni, e lo fa da più di un anno.
Il Segretario generale delle Nazioni Unite António Guterres…
Continua su https://zeitun.info/2024/12/ 20/lettera-aperta-di- matematici-contro-il- genocidio-a-gaza/
Boicottaggio natalizio a Carrefour
Si è tenuta la giornata nazionale di boicottaggio a Carrefour, un’iniziativa lanciata da BDS* Italia per denunciare le complicità di Carrefour con il genocidio in corso a Gaza e il sistema di apartheid israeliano. L’obiettivo è sensibilizzare l’opinione pubblica e fare pressione affinché Carrefour interrompa collaborazioni con aziende coinvolte nella colonizzazione illegale israeliana.
Carrefour è accusata di complicità attraverso partnership con aziende israeliane come Electra Consumer Products e Yenot Bitan, entrambe coinvolte nella colonizzazione illegale. Una filiale Carrefour risulta aperta a Modi’in-Maccabim-Re’ut, una colonia illegale secondo il diritto internazionale. Inoltre, a maggio 2023, Carrefour ha stretto collaborazioni con sei start-up israeliane che operano nei settori dell’intelligenza artificiale e della cybersecurity. Non solo: l’azienda è accusata di sostenere l’esercito israeliano fornendo gratuitamente razioni alimentari, aggravando il genocidio in corso a Gaza.
* BDS Italia – sezione italiana per il movimento a guida palestinese per il boicottaggio, disinvestimento e sanzioni contro Israele. Clicca qui.
La Regione Lombardia, molto previdente, ha disposto 30 microdepositi sul territorio regionale dedicati allo stoccaggio di ioduro di potassio quale “antidoto da distribuire alla popolazione”: lo iodio, infatti, assiste il funzionamento della tiroide nel caso di esposizione alle radiazioni nucleari. La delibera è, appunto, “in considerazione delle crescenti preoccupazioni per il potenziale rilascio di sostanze radioattive causate dagli scontri in Ucraina”. Per un bresciano, infatti, è evidente la connessione tra un attacco missilistico russo e il grande deposito di bombe nucleari americane a Ghedi – in provincia – da poco ammodernate e rese aviotrasportabili. Ma anche altre Regioni dovrebbero attrezzarsi in tal senso.
“Qui non ci sono i pesci grossi”
Papa Francesco entrando nel carcere di Rebibbia.
A Genova è stato installato un “presepe morente”, durante un flashmob, che ha voluto commemorare i più degli 800 neonati uccisi nella Striscia di Gaza in quattordici mesi. I neonati sepolti sotto le macerie che cercano l’ultimo respiro e quelli morti per mancanza di cure, per malnutrizione e malattie respiratorie a causa dei bombardamenti israeliani sugli ospedali nella totale violazione del diritto internazionale.
Sono stati sparsi fagottini bianchi macchiati di pittura rosso sangue ancora fresca, nella piazza principale della città, tra il Palazzo Ducale, la Regione Liguria coperti di luminarie e il classico mercatino natalizio di baite che, con i cartelloni pubblicitari che invitano agli acquisti, hanno provocato un grande contrasto con il presepe morente.
Summit mondiale premi Nobel per la pace
Dopo quattro giorni dinamici e stimolanti, il 19esimo vertice mondiale dei premi Nobel per la Pace a Monterrey nel Messico si è chiuso con successo. E nel 2024 il premio Nobel per la pace è assegnato all’organizzazione giapponese Nihon Hidankyo, formata dai sopravvissuti alle devastazioni avvenute ad Hiroshima e a Nagasaki, per un mondo libero dalle armi nucleari. Clicca qui.
Non possiamo più dirci cristiani
La dimensione della misericordia, dell’accoglienza e della pace, è stata messa da parte nel mondo occidentale: ha scelto sciaguratamente la via delle armi per la soluzione dei conflitti, ha privilegiato il riarmo al disarmo, tagliando le spese sociali, in particolare quelle per l’istruzione e per la salute.
Ha preferito chiudere i porti e le frontiere, respingere i profughi che fuggono dalle guerre e i migranti costretti a lasciare le loro dimore a causa delle carestie, dei cambiamenti climatici, della devastazione delle foreste. L’Europa chiusasi in fortezza, come se fosse assediata da eserciti, ha fatto sì che il Mediterraneo diventasse un enorme cimitero.
Il Parlamento italiano ha emanato leggi che riducono il migrante irregolare a delinquente, e creato i CpR, centri di detenzione peggiori delle carceri. Un ministro del governo ha impedito a navi piene di naufraghi, salvati da morte sicura, di approdare al porto più vicino, lasciandoli per giorni e giorni in condizioni disumane. Salvini, il ministro del nostro Paese che “difende i confini” dall’“invasione” di naufraghi, negando il diritto umano al soccorso in mare e sequestrando persone innocenti che non hanno commesso alcun crimine, è assolto dal giudizio di un tribunale umano. Non potranno essere assolti, tuttavia, lui e il Paese che rappresenta, da ogni coscienza umana che crede nella giustizia.
Un’Europa che non si adopera per mettere fine al massacro genocida che si perpetua nella Striscia di Gaza, dove decine di migliaia di bambine/i sono vittime innocenti, come può dirsi cristiana, come può celebrare il Natale? Clicca qui.
Nel frattempo, si accumulano altre prove che Gaza non sta subendo solo un assalto che viola la legge e i diritti umani, ma uno storico genocidio. Secondo Airwars, un’organizzazione che monitora le vittime civili: “Il danno ai civili dal primo mese della campagna israeliana a Gaza è incomparabile con qualsiasi campagna aerea del 21° secolo”. La visione di diversi mesi di sforzi di ricerca è integrata dalle confessioni e dalle testimonianze del personale militare israeliano. Il quotidiano israeliano Haaretz ha pubblicato resoconti di soldati dell’IDF che hanno prestato servizio a Gaza, affermando che i civili, persino i bambini, vengono trattati come combattenti. Il regime di uccisioni arbitrarie, persino competitive, è stato descritto come “il selvaggio West sotto steroidi”.
Queste descrizioni non si limitano a descrivere metodi di combattimento legali e militari, ma descrivono anche uccisioni, carestie, mutilazioni, torture e traumi psicologici impossibili da comprendere.
Queste indagini rivelano le permutazioni del dolore che può essere inflitto a una popolazione civile. Piccoli corpi spezzati, bambini in putrefazione, cadaveri appiattiti, fosse comuni, quartieri rasi al suolo e il dolore selvaggio dei parenti in lutto. È uno spettacolo di massacro. Tutto si svolge in bella vista, trasmesso in streaming e pubblicato da cittadini e giornalisti palestinesi, assistito da estranei e descritto dagli stessi israeliani.
Nonostante le prove schiaccianti che abbiamo davanti a noi, ancora nulla cambia. La guerra continua. Cose che sembravano delle svolte, come la prima udienza della Corte internazionale di giustizia (ICJ), ora sembrano esercizi di osservazione. Perfino il Papa viene tacciato di antisemitismo.
Aspettando Trump. Guerra fino all’ultimo. All’ultimo ucraino
I ministri degli Esteri dell’Unione europea hanno varato il 15° pacchetto di aiuti per l’Ucraina e nuove sanzioni per Mosca. Per la guerra, iniziata ormai quasi tre anni fa con l’invasione russa, non sembra ci siano prospettive di tregua. Per la prima volta, il Consiglio Ue ha deciso di imporre misure restrittive contro 16 persone e tre entità per rispondere alle attività destabilizzanti della Russia contro l’Ue, i suoi Stati membri e i suoi partner. Tra le designazioni si conta anche l’Unità GRU 29155, un’unità segreta dell’agenzia di intelligence militare russa (GRU), nota per il suo coinvolgimento in omicidi stranieri e attività di destabilizzazione come attentati e attacchi informatici in tutta Europa. Sul fronte opposto, il presidente russo Putin accusa Kiev di compiere un nuovo “crimine” abbassando l’età della leva dai 25 ai 18 anni, come chiesto dagli Usa. “Anche se l’abbassassero a 14 anni, non cambierà la situazione sul campo di battaglia”. Putin ha anche puntato il dito contro gli Stati Uniti: “Nella loro volontà di indebolire il nostro Paese, di infliggerci una sconfitta strategica, gli Usa continuano a pompare il regime illegittimo di Kiev di armi e soldi, inviano mercenari e consulenti militari, incoraggiando l’escalation del conflitto”.
Obiezione di coscienza in arabo e ebraico
È scritta in arabo, ebraico, italiano, la Dichiarazione congiunta dei tre movimenti (CPT – Palestine, Mesarvot – Israel e Movimento Nonviolento – Italia) che lavorano insieme come gruppo misto per l’obiezione alla guerra.
Da oggi il documento (che non è il solito appello, ma un’assunzione di responsabilità e impegno) viene diffuso a livello internazionale anche in inglese. Clicca qui.
Anche il DDL sicurezza non ci fermerà
Per le associazioni che si occupano di ambiente, il bilancio del 2024 è disastroso: crisi climatica, eventi estremi, diseguaglianze sociali, repressione del dissenso, decreto sicurezza.
Clicca qui
Extinction Rebellion, Fridays for Future, Ultima Generazione, Greenpeace Italia, Rete Italiana Pace e Disarmo, Coordinamento FreeItalia solare, Isde, Associazione Medici per l’Ambiente, Cittadini per l’Aria.
E clicca sempre il Sito del Movimento di lotta per la salute Maccacaro: www.rete-ambientalista.it
Forum Italiano dei Movimenti per l’Acqua
Report Riunione Coordinamento Nazionale.
O.d.G: ricorso CEDU comunicazione del Prof. Lucarelli, discussione su emendamento alla legge finanziaria di privatizzazione del servizio idrico – discussione su mobilitazione sulla crisi idrica nel meridione. Clicca qui.
FIRMA:
Stop ai finanziamenti pubblici alle cliniche private
Lo Stato italiano riconosca quello palestinese
Diciamo stop ai fuochi d’artificio
Scopri tutte le altre petizioni lanciate sulla piattaforma
11 Marzo 2025